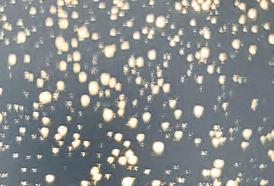

![]()































Welcome to the 2024 Directory, a fresh new look for ultimate inspiration.
Explore our collection of over 1200 products including lots of new ranges from our dedicated team of British based designers. Let the Endon Directory light up your interior and exterior home spaces.
EIGHTY YEARS
L IGHTING HERITAG









Endon designers take great care with the colours used in the Directory. The limitations of the printing process may mean a slight variation in colour. Every reasonable care has been taken to ensure the reproductions are accurate. Descriptions in the catalogue are approximate only. Due to the nature of the product and its manufacture, there may be variations in materials, colour, size and finish.
Our natural stone, marble and concrete products are sold on the basis of your acceptance of the terms of this disclaimer. All these types of products contain natural stone elements and there will be variations in texture, colour, veining and patterns. These variations are not flaws, they create the uniqueness of each product. Please note that the appearance of the actual products may di er from the images shown due to these variations.
We always seek to improve our product and reserve the right to make changes at any time without notice. This catalogue supersedes all previous issues.
Endon Lighting are proud to be partnered and associated with the organisations shown below.
All copyright, design right and other intellectual property rights in our designs and in our products (and in the images, text and design of this brochure) are and will remain the property of Endon Lighting Ltd. Any infringement of these rights will be pursued vigorously.
We are doing everything we can to be as green as possible. Our paper is FSC®-certified, meaning it is sourced with responsible forestry practices. Additionally, we are carbon balanced by the World Land Trust, so we reduce the impact of our carbon emissions. On top of that, our printer W&G Baird, uses vegetable-based inks, furthering our environmental sustainability.





















































Understated glamour featuring detailed glass and timeless finishes

glamour








Bring nature home with earthy materials of bamboo and rattan, ideal for creating a warming ambience






for










Choose classic lighting with a hint of modern overtones for a relaxed, stylish interior




















High quality detailed resin figurine table lights to add character and fun










Knurled details and exposed lamps create this rustic casual look, perfect for modern and traditional interiors alike



















































































1. Berenice 5lt Pendant 104108
Bright nickel plate & clear glass
H: 620-2000 Dia: 510mm
5 x E14
3. Berenice 3lt Semi Flush 104107
Bright nickel plate & clear glass
Proj: 410 Dia: 456mm 3 x E14
5. Berenice Wall 104109
Bright nickel plate & clear glass
Proj: 185 W: 105 H: 215mm E14
2. Berenice 5lt Pendant 107802
Antique brass plate & clear glass
H: 620-2000 Dia: 510mm
5 x E14
4. Berenice 3lt Semi Flush 107801
Antique brass plate & clear glass
Proj: 410 Dia: 456mm 3 x E14
6. Berenice Wall 107803
Antique brass plate & clear glass
Proj: 185 W: 105 H: 215mm E14 in AUTUMN / WINTER 23


1. Allegra 8lt Pendant 104051
Bright nickel plate & clear spiral glass
Proj: 355-655 Dia: 770mm
8 x E14
104050
5. Allegra Wall 104052
Proj: 160 H: 230 W: 120mm E14

2. Allegra 8lt Pendant 103172
Antique brass plate & clear spiral glass
H: 355-655 Dia: 770mm
8 x E14
4. Allegra 6lt Semi Flush 103171
Antique brass plate & clear spiral glass
Proj: 330 Dia: 640mm
6 x E14
6. Allegra Wall 103173





Antique brass plate & clear spiral glass Proj: 160 H: 230 W: 120mm E14 in AUTUMN / WINTER 23






Clear ribbed glass panels beautifully diffuse the light; set against antique brass metal work to create a sophisticated timeless design.







1. Hopton Flush 101540
Matt black & clear glass
Proj: 215 Dia: 310mm E27
4. Hopton Wall 104193
Matt black & clear glass
Proj: 185 H: 250 W: 145mm E14
2. Hopton Flush 96150
Bright nickel plate & clear glass
Proj: 215 Dia: 310mm E27
5. Hopton Wall 106003
Bright nickel plate & clear glass
Proj: 185 H: 250 W: 145mm E14
3. Hopton Flush 103112




















3. Oscar 11lt Pendant 76500
H: 720-2020 Dia: 558mm
Brushed brass plate & gloss white glass
H: 720-1635 Dia: 550mm
4. Oscar 6lt Semi Flush 76501
Brushed brass plate & gloss white glass
Proj: 370 Dia: 498mm
Black chrome plate & smoked mirror glass
Proj: 370 Dia: 498mm



On trend black chrome plate metalwork with beautiful smoked mirror glass shades

authentic
Finished in a range of aged metals with authentic knurled lamp holder details and clear glass shades. Pair with filament LED lamps for that perfect industrial style.













1. Hansen Grand Pendant 106895
Aged copper plate & clear glass H: 450-1520 Dia: 330mm E27
3. Hansen Pendant 76332
Aged copper plate & clear glass H: 400-1270 Dia: 225mm E27
5. Hansen Wall 76334
Aged copper plate & clear glass Proj: 275 H: 220 W: 150mm E14
7. Hansen Task Table 77861
Aged copper plate & clear glass H: 533 W: 150 D: 300mm E14
9. Hansen Task Floor 77862
Aged copper plate & clear glass H: 1520 W: 280 D: 460mm E27
2. Hansen Grand Pendant 106896
Brushed silver paint & clear glass H: 450-1520 Dia: 330mm E27
4. Hansen Pendant 91738
Brushed silver paint & clear glass H: 400-1270 Dia: 225mm E27
6. Hansen Wall 91739
Brushed silver paint & clear glass Proj: 275 H: 220 W: 150mm E14
8. Hansen Task Table 91740
Brushed silver paint & clear glass H: 533 W: 150 D: 300mm E14
10. Hansen Task Floor 91741
Brushed silver paint & clear glass H: 1520 W: 280 D: 460mm E27










1. Hansen Grand Pendant 102926
Antique brass plate & clear glass
H: 450-1520 Dia: 330mm E27
5. Hansen 3lt Semi Flush 97247
Antique brass plate & clear glass
Proj: 160-210 Dia: 500-700mm
3 x E14
2. Hansen Pendant 77272
Antique brass plate & clear glass H: 400-1270 Dia: 225mm E27
6. Hansen 5lt Semi Flush 97248
Antique brass plate & clear glass
Proj: 190-210 Dia: 650-840mm 5 x E14

3. Hansen 3lt Linear Pendant 98114
Antique brass plate & clear glass H: 370-1770 L: 1025 W: 225mm 3 x E27
7. Hansen Task Table 77859
Antique brass plate & clear glass H: 533 W: 150 D: 300mm E14

4. Hansen Wall 77273
Antique brass plate & clear glass
Proj: 275 H: 220 W: 150mm E14
8. Hansen Task Floor 77860
Antique brass plate & clear glass H: 1520 W: 280 D: 460mm E27







1. Mathias 3lt Linear Pendant 101698
Dark bamboo & plywood with matt black paint
H: 380-1485 L: 1015 W: 220mm 3 x E27
3. Mathias Pendant 101700
Dark bamboo & plywood with matt black paint
H: 380-1485 Dia: 220mm E27
5. Mathias Flush 101699
Dark bamboo & plywood with matt black paint
Proj: 230 Dia: 405mm E27
7. Mathias Table 101674
Dark bamboo & plywood with matt black paint
H: 270 Dia: 225mm E27
9. Mathias Floor 101697
Dark bamboo & plywood with matt black paint
H: 1280 Dia: 450mm E27
2. Mathias 3lt Linear Pendant 101775
Natural bamboo, plywood & matt black paint H: 380-1485 L: 1015 W: 220mm 3 x E27
4. Mathias Pendant 101777
Natural bamboo, plywood & matt black paint H: 380-1485 Dia: 220mm E27
6. Mathias Flush 101776
Natural bamboo, plywood & matt black paint Proj: 230 Dia: 405mm E27
8. Mathias Table 101773
Natural bamboo, plywood & matt black paint H: 270 Dia: 225mm E27
10. Mathias Floor 101774
Natural bamboo, plywood & matt black paint H: 1280 Dia: 450mm E27












Simple and stylish sustainably sourced bamboo cage, creating a soft warm light. Finshed in either natural or dark bamboo.









Sustainably sourced natural light wood with matt black collection; pair with LED lamp of your choice to create a unique contemporary lighting feature.
Add some texture in your home with this woven natural seagrass collection.






















Embodying the natural, cosy and minimalist characteristics of scandi design, this collection emits a warming glow.


1. Durban 3lt Linear Pendant 101681
Natural eucalyptus wood, natural linen & matt black
H: 350-1300 L: 800 W: 200mm
3 x E27
2. Durban Table 101680
Natural eucalyptus wood, natural linen & matt black
H: 300 Dia: 200mm E27
2. Cordero 3lt Flush 101568
4. Cordero 3lt Flush 81966
Proj: 260 Dia: 430mm






Geometric fretwork metal outer frame with an inner fabric shade.

















Vintage white shades with metallic inners beautifully disperse the light.





Pair with filament LED lamps for the latest on-trend vintage look.












1. Hal 12lt Pendant 81609
Aged copper & aged pewter plate
H: 630-980 Sq: 590mm 12 x E27
5. Hal 3lt Semi Flush 76124
Aged pewter & aged copper plate
Proj: 130 Dia: 355-500mm 3 x E27
9. Hal Wall 92866
Aged pewter & aged copper plate
Proj: 234-320 H: 273 W: 170mm E27
2. Hal 6lt Pendant 76337
Aged pewter & aged copper plate
H: 275-800 Dia: 540mm 6 x E27
6. Hal 3lt Pendant 92988
Clear glass, aged copper & pewter plate
H: 600-1658 Dia: 400mm 3 x E27
10. Hal Wall 92874
Aged pewter, aged copper plate & clear glass
Proj: 234-320 H: 267 W: 170mm E27
3. Hal 8lt Semi Flush 81610
Aged copper & aged pewter plate
Proj: 143 W: 680 L: 950mm 8 x E27
7. Hal Table 76339
Aged pewter & aged copper plate H: 453 W: 140 D: 165mm E27
11. Hal Wall 76338
Aged pewter & aged copper plate
Proj: 172-240 H: 152 W: 120mm E27
4. Hal 5lt Semi Flush 76336
Aged pewter & aged copper plate
Proj: 130 Dia: 405-550mm 5 x E27
8. Hal Table 76355
Aged pewter & aged copper plate
H: 96 Dia: 140mm E27









H: 275-800 Dia: 540mm
x E27
405-550mm 5 x E27
brass plate H: 453 W: 140 D: 165mm E27








1. Franklin Large Pendant 98749
Aged pewter plate & matt black paint
H: 400-1565 Dia: 335mm E27
2. Franklin Large Pendant 98744
Antique brass plate
H: 400-1565 Dia: 335mm E27
3. Franklin Large Pendant 76327 Taupe & antique brass plate
H: 400-1420 Dia: 335mm E27
4. Franklin Small Pendant 98750
Aged pewter plate & matt black paint
H: 400-1460 Dia: 235mm E27
5. Franklin Small Pendant 98745
Antique brass plate
H: 400-1460 Dia: 235mm E27
6. Franklin Small Pendant 76328
Taupe & antique brass plate
H: 400-1460 Dia: 235mm E27
7. Franklin Wall 98751
Aged pewter plate & matt black paint
Proj: 250 H: 197 W: 150mm E14
8. Franklin Wall 98746
Antique brass plate
Proj: 250 H: 197 W: 150mm E14
9. Franklin Wall 76330
Taupe & antique brass plate
Proj: 250 H: 197 W: 150mm E14
10. Franklin Task Table 98752
Aged pewter plate & matt black paint
H: 460 W: 150 D: 290mm E14
11. Franklin Task Table 98747
Antique brass plate
H: 460 W: 150 D: 290mm E14
12. Franklin Task Wall 98560
Aged pewter plate & matt black paint
Proj: 230 W: 150 H: 225mm E14
13. Franklin Task Floor 98753
Aged pewter plate & matt black paint
H: 1600 W: 280 D: 350mm E27
14. Franklin Task Floor 98748
Antique brass plate & matt black paint
H: 1600 W: 280 D: 350mm E27


















Knurled details and contrasting finishes.




Smart metallic range with mirrored glass.
1. Caspa 3lt Linear Pendant 100047
Bright nickel plate & mirrored glass
H: 280-1380 L: 700 W: 160mm
3 x E14
3. Caspa Wall 100044
Bright nickel plate & mirrored glass
Proj: 245-310 H: 180 W: 160mm E14
5. Caspa Task Floor 100045
Bright nickel plate & mirrored glass
H: 1440 W: 280 D: 470-580mm E27


2. Caspa Pendant 100046
Bright nickel plate & mirrored glass
H: 350-1445 Dia: 270mm E27
4. Caspa Task Table 100043
Bright nickel plate & mirrored glass
H: 495-560 W: 160-240 D: 290-350mm E14











Decorative collection with ribbed glass shades and stylish curved arms.
1. Mesmer 6lt Pendant 99607
Chrome plate, clear glass with clear glass beads
H: 400-1355 Dia: 320mm 6 x G9
2. Mesmer 5lt Semi Flush 99570
Chrome plate, clear glass with clear glass beads
Proj: 160 Dia: 520mm 5 x G9
Chrome plate, clear glass with clear glass beads
Proj: 160 Dia: 510mm 3 x G9
4. Mesmer Table 99572
Chrome plate, clear glass with clear glass beads
H: 405 W: 180 D: 130mm G9
















Adjustable height

1. Dimple 5lt Pendant 97972
Chrome plate & smoked mirror glass
H: 465-620 Dia: 590mm 5 x E14
5. Dimple 5lt Pendant 91972
Satin brass plate & champagne lustre glass
H: 800-1375 Dia: 310mm 5 x E14
9. Dimple Wall 91970
Proj: 198 W: 145 H: 240mm E14
2. Dimple 3lt Semi Flush 97971
Chrome plate & smoked mirror glass
Proj: 295 Dia: 520mm 3 x E14
6. Dimple 3lt Pendant 91971
Satin brass plate & champagne lustre glass H: 550-1375 Dia: 310mm 3 x E14
10. Dimple Table 91973
H: 156 Dia: 150mm E14



3. Dimple Table 97976
Chrome plate & smoked mirror glass
H: 156 Dia: 150mm E14
7. Dimple 5lt Pendant 91969
465-620 Dia: 590mm 5 x E14
11. Dimple 3lt Floor 91974
3
Chrome plate & smoked mirror glass
H: 1500 W: 250 D: 280mm E27
8. Dimple 3lt Semi Flush 91968
Proj: 295 Dia: 520mm 3 x E14
12. Dimple Floor 98271
H: 1500 W: 250 D: 280mm E27






1. Talia 5lt Pendant 77566
Chrome plate & clear crystal
H: 300-1200 Dia: 240mm
Chrome plate & clear crystal H: 360 W: 130 D: 157mm
2. Talia 5lt Semi Flush 76595
Chrome plate & clear crystal Proj: 165 Dia: 560mm 5
4. Talia Wall 77567
Chrome plate & clear crystal Proj: 180 H: 100 W: 118mm G9
Chrome







1. Aerith 12lt Pendant 76315
Chrome plate & smoked mirror glass
H: 600-1770 Dia: 540mm
12 x G9
4. Aerith 2lt Wall 73583
Chrome plate & smoked mirror glass
Proj: 140 H: 300 W: 250mm 2 x G9


2. Aerith 6lt Semi Flush 73582
Chrome plate & smoked mirror glass
Proj: 220 Dia: 680mm 6 x G9
5. Aerith 2lt Touch Table 76125
Chrome plate & smoked mirror glass
H: 400 W: 280 D: 140mm 2 x G9

3. Aerith 3lt Semi Flush 73642
Chrome plate & smoked mirror glass
Proj: 145 Dia: 475mm 3 x G9
6. Aerith 2lt Floor 76123
Chrome plate & smoked mirror glass H: 1520 Dia: 280mm 2 x G9













Combining timeless natural linen or sumptuous green velvet with understated brushed bronze, antique brass or satin nickel metalwork.
Pair with LED filament lamp to complete the look.






1. Hoop 5lt Pendant 81923
Brushed brass, nickel & copper plate
H: 1100-2000 W: 456 D: 250mm 5 x E27
5. Hoop Pendant 90454
Brushed nickel plate
H: 300-1200 W: 250 D: 100mm E27
9. Hoop Table 97665
Brushed brass, nickel & copper plate
H: 250 W: 250 D: 100mm E27
2. Hoop 3lt Pendant 81922
Brushed brass, nickel & copper plate
H: 700-1200 W: 388 D: 220mm 3 x E27
6. Hoop Pendant 90456
Brushed copper plate
H: 300-1200 W: 250 D: 100mm E27
10. Hoop Floor 98095
Brushed brass, nickel & copper plate
H: 1480 Dia: 250mm E27





3. Hoop Pendant 97664
Brushed brass, nickel & copper plate
H: 300-1200 W: 250 D: 100mm E27
7. Hoop 6lt Semi Flush 91935
Brushed brass, nickel & copper plate
Proj: 332 Dia: 590mm 6 x E27
11. Hoop Floor 91934
Brushed brass plate
H: 1490 Dia: 250mm E27
4. Hoop Pendant 81921
Brushed brass plate
H: 300-1200 W: 250 D: 100mm E27
8. Hoop 3lt Semi Flush 97663
Brushed brass, nickel & copper plate
Proj: 151 Dia: 552 mm 3 x E27









Create a stunning centrepiece in any interior space.












Clear crystal glass & chrome plate
H: 550-1470 Dia: 410mm
5 x G9
4. Acadia 6lt Pendant 81931
Chrome plate & clear crystal
H: 500-1100 Sq: 530mm
6 x E14
Clear crystal glass & chrome plate
Proj: 220 Dia: 360mm 4 x G9
5.
Chrome plate & clear crystal
H: 500-1100 Sq: 354mm 4 x E14

Clear crystal glass & chrome plate
Proj: 110 H: 200 W: 180mm G9
Chrome plate & clear crystal
Proj: 150 H: 300 D: 230mm E14
An opulent and ornate silver & gold leaf finished floral collection.















1. Delphine 3lt Pendant 76360 Gold leaf H: 505-1405 Dia: 450mm 3 x E14
2. Delphine Pendant Small 95035 Gold leaf H: 500-1585 Dia: 350mm E27
3. Delphine 3lt Flush 95039 Gold leaf Proj: 350 Dia: 465mm 3 x E14
4. Delphine Wall 95040 Gold leaf & ivory cotton fabric
H: 360 Proj: 200 W: 135mm E14
5. Delphine Table 95037 Gold leaf & ivory cotton fabric H: 550 Dia: 355mm E27
6. Delphine 3lt Pendant 76678
7. Delphine Pendant Small 98044
H: 500-1585 Dia: 350mm E27
8. Delphine 3lt Flush 98048
leaf Proj: 350 Dia: 465mm 3 x E14
9. Delphine Wall 98049
H: 360 Proj: 200 W: 135mm E14
10. Delphine Table 98046









































1. Zelma Pendant 92176
Satin brass plate & gold effect chain
H: 500-1700 Dia: 450mm
20W Int. LED 480 lumens warm white
5. Zelma Table 92177
Satin brass plate & gold effect chain
H: 400 Dia: 220mm
9W Int. LED 250 lumens warm white
2. Zelma Pendant 92178
Brushed copper plate & copper effect chain
H: 500-1700 Dia: 450mm
20W Int. LED 480 lumens warm white
6. Zelma Table 92179
Brushed copper plate & copper effect chain
H: 400 Dia: 220mm
9W Int. LED 250 lumens warm white


3. Zelma Pendant 73768
Chrome plate & silver effect chain
H: 500-1700 Dia: 450mm
20W Int. LED 480 lumens warm white
7. Zelma Table 73769
Chrome plate & silver effect chain
H: 400 Dia: 220mm
9W Int. LED 250 lumens warm white

4. CCT Pendant. Turn on/off, dimmable, flash mode, change colour between warm white, cool white & daylight white.
4. Zelma CCT Pendant 97368
Chrome plate & silver effect chain
H: 500-1700 Dia: 450mm
20W Int. LED 780 lumens CCT
Supplied with CCT remote control
















5
Chrome plate & clear crystal
Proj: 260 Dia: 355mm 5 x G9

Chrome plate & clear crystal H: 1580 Dia: 260mm 3 x G9
Chrome plate & clear crystal
Proj: 100 H: 152 W: 202mm G9
















1. Fargo 6lt Pendant FARGO-18CH
Chrome plate & clear acrylic H: 420-1830 Dia: 460mm 6 x E14
3. Fargo 3lt Pendant FARGO-14CH
Chrome plate & clear acrylic H: 335-1510 Dia: 390mm 3 x E14
5. Fargo 3lt Pendant FARGO-12CH
Chrome plate & clear acrylic H: 335-1480 Dia: 310mm 3 x E14
7. Fargo 2lt Flush FARGO-CH
Chrome plate & clear acrylic Proj: 300 Dia: 240mm 2 x E14
9. Fargo 2lt Wall FARGO-WBCH
Chrome plate & clear acrylic
Proj: 162 H: 280 W: 265mm 2 x E14
2. Fargo 6lt Pendant FARGO-18BP
Brass plate & clear acrylic
H: 420-1830 Dia: 460mm 6 x E14
4. Fargo 3lt Pendant FARGO-14BP
Brass plate & clear acrylic H: 335-1510 Dia: 390mm 3 x E14
6. Fargo 3lt Pendant FARGO-12BP
Brass plate & clear acrylic H: 335-1480 Dia: 310mm 3 x E14
8. Fargo 2lt Flush FARGO-BP
Brass plate & clear acrylic Proj: 300 Dia: 240mm 2 x E14
10. Fargo 2lt Wall FARGO-WBBP
Brass plate & clear acrylic
Proj: 162 H: 280 W: 265mm 2 x E14

Stunning pendants to give modern interiors a designer look.






1. Orta 9lt Pendant 70575
2. Orta 6lt Semi Flush 98126 Satin brass plate Proj: 480 Dia: 540mm 6 x G9











Chrome plate & white silicone
Proj: 150 Dia: 600mm
43.5W Int. LED 2500 lumens warm white
H: 500-1845 Dia: 620mm
47.5W Int. LED 2610 lumens warm white
Chrome plate & white silicone
Proj: 150 W: 570 D: 300mm
32W Int. LED 1600 lumens warm white
Textured black & white silicone
H: 200 Dia: 535mm
42W Int. LED 2350 lumens warm white
Chrome plate & white silicone
H: 300 W: 285 D: 170mm
17W Int. LED 800 lumens warm white



1. Eternity 3lt Pendant 74729
Matt nickel plate & clear crystal
H: 650-2000 H: 465 Dia: 500mm
42W Int. LED 1800 lumens warm white
4. Lorenzo 4lt Pendant 97614
Satin gold paint & clear acrylic
H: 450-1800 Dia: 740mm
48w Int. LED 3200 lumens warm white



2. Eternity Pendant 72969
Matt nickel plate & clear crystal glass
H: 360-1770 Dia: 700mm
42W Int. LED 2100 lumens warm white
5. Lorenzo 4lt Semi Flush 97617
Satin gold paint & clear acrylic
Proj: 340 Dia: 600mm
42w Int. LED 2350 lumens warm white

3. Eternity Touch Table 73048
Matt nickel plate & clear crystal glass
H: 465 W: 450 D: 80mm
26W Int. LED 1100 lumens warm white
6. Lorenzo Wall 97611
Satin gold paint & clear acrylic
W: 350 H: 45 Proj: 145mm
7.5w Int. LED 400 lumens warm white











1. Muni Pendant MUNI-CH
Chrome plate with clear & chrome glass
H: 715-1780 Dia: 480mm
8.53W Int. LED 558 lumens warm white
5. Muni Flush MUNI-CH-F
Chrome plate with clear & chrome glass
Proj: 280 Dia: 470mm
6.3W Int. LED 432 lumens warm white
2. Muni Pendant MUNI-CH-S
Chrome plate with clear & chrome glass
H: 545-1710 Dia: 390mm
6.3W Int. LED 426 lumens warm white
6. Muni Flush MUNI-CO-F
Copper plate with clear & copper glass
Proj: 280 Dia: 470mm
6.3W Int. LED 402 lumens warm white

3. Muni Pendant MUNI-CO
Copper plate with clear & copper glass
H: 715-1780 Dia: 480mm
8.53W Int. LED 483 lumens warm white
7. Muni Table MUNI-TLCH
Chrome plate with clear & chrome glass
H: 325 Dia: 280mm
6.89W Int. LED 513 lumens warm white
4. Muni Pendant 102608
Gold effect plate with clear & gold glass
H: 715-1980 Dia: 480mm
8.53W LED 539 lumens warm white
8. Muni Table 102609
Gold effect plate with clear & gold glass
H: 325 Dia: 280mm
6.89W LED 552 lumens warm white


Spheres suspended at various heights creating a stunning modern design









Create striking light patterns with an intricate mix of thousands of high quality crystals.







Pendant or flush fittings with smooth oval lines, creating a contemporary designer look.


1. Ovals 4lt Linear Pendant 97628
Textured black & white silicone
H: 500-1750 L: 1075 D: 80mm
43W Int. LED 1950 lumens warm white
2. Ovals 4lt Flush 97626
Textured black & white silicone
Proj: 60 W: 335 L: 835mm
43W Int. LED 1750 lumens warm white





















This collection is a restrained balance of gloss blown opal glass shades and satin brass metalwork.









1. Rubens 6lt Pendant 77114 Satin brass plate H: 645-1600 Dia: 600mm 6 x E27
2. Rubens 6lt Semi Flush 79469 Chrome plate H: 405 Dia: 410mm 6 x E27
3. Rubens Table 76344
plate H: 450 W: 150 D: 240mm E27
4. Rubens Table 77117
150 D: 240mm
Floor 76983





1. Toledo Pendant 90563














1. Eclipse 5lt Pendant 78697
Chrome plate glass & clear glass
H: 550-1460 Dia: 400mm
5 x G9
2. Eclipse 3lt Flush 78696
Chrome plate glass & clear glass
Proj: 170 Dia: 280mm
3 x G9
3. Stellar Pendant 74939
Chrome holographic glass & chrome plate
H: 400-1300 Dia: 220mm
E27
4. Stellar Touch Table 74940
Chrome holographic glass & chrome plate
H: 240 Dia: 165mm
E14

1. Highclere 8lt Pendant 99152
Brushed chrome plate & natural linen
H: 550-1745 Dia: 700mm
8 x E14
5. Highclere 3lt Table 94369
Brushed chrome plate & natural fabric
H: 500 Dia: 320mm 3 x E14
9. Highclere 6lt Pendant 94381
Bright nickel plate & charcoal fabric
H: 500-1855 Dia: 537mm
6 x E14
13. Highclere 3lt Table 99149
Bright nickel plate & charcoal fabric
H: 500 Dia: 320mm
3 x E14




2. Highclere 6lt Pendant 94357
Brushed chrome plate & natural fabric H: 350-1740 Dia: 550mm 6 x E14
6. Highclere Table 100646
Brushed chrome plate & natural linen
H: 447 Dia: 250mm E14
10. Highclere 6lt Pendant 94373
Bright nickel plate & charcoal fabric
H: 350-1740 Dia: 550mm 6 x E14
14. Highclere 3lt Floor 94378
Bright nickel plate & charcoal fabric H: 1600 Dia: 470mm 3 x E14




3. Highclere 6lt Pendant 99151
Brushed chrome plate & natural linen H: 500-1855 Dia: 537mm 6 x E14
7. Highclere 3lt Floor 94359
Brushed chrome plate & natural fabric H: 1600 Dia: 470mm 3 x E14
11. Highclere 3lt Pendant 94377
Bright nickel plate & charcoal fabric
H: 350-1420 Dia: 450mm 3 x E14
15. Highclere 6lt Pendant 94397
Bright nickel plate & charcoal fabric H: 300-1740 Dia: 550mm 6 x E14




4. Highclere 2lt Wall 94403
Brushed chrome plate & natural fabric
Proj: 180 H: 250 W: 350mm 2 x E14
8. Highclere 8lt Pendant 94415
Bright nickel plate & charcoal fabric
H: 550-1745 Dia: 700mm 8 x E14
12. Highclere 2lt Wall 94406
Bright nickel plate & charcoal fabric
Proj: 180 H: 250 W: 350mm 2 x E14
16. Highclere 3lt Pendant 94394
Bright nickel plate & charcoal fabric
H: 300-1420 Dia: 450mm 3 x E14

A sophisticated combination of neutral fabrics and bright nickel metalwork.
H: 350-1420 Dia: 450mm 3 x E14
Stunning vintage white shades complement antique brass metal work creating a distinguished look.













1. Highclere 8lt Pendant 98938
Antique brass plate & vintage white fabric
H: 550-1745 Dia: 700mm 8 x E14
3. Highclere 6lt Pendant 98936
Antique brass plate & vintage white fabric
H: 500-1855 Dia: 537mm 6 x E14
5. Highclere 3lt Table 98932
Antique brass plate & vintage white fabric
H: 500 Dia: 320mm 3 x E14
7. Highclere 2lt Wall 98937
Antique brass plate & vintage white fabric
Proj: 180 H: 250 W: 350mm 2 x E14
2. Highclere 6lt Pendant 98933
Antique brass plate & vintage white fabric
H: 350-1740 Dia: 550mm 6 x E14
4. Highclere 3lt Pendant 98934
Antique brass plate & vintage white fabric
H: 350-1420 Dia: 450mm 3 x E14
6. Highclere Table 104054
Antique brass plate & vintage white fabric H: 447 Dia: 250mm E14
8. Highclere 3lt Floor 98935
Antique brass plate & vintage white fabric H: 1600 Dia: 470mm 3 x E14








Once lit, each crystal combines to create an intensified decorative light effect.



H: 500-2120 Dia: 620mm 8 x E14










1. Verina Pendant 76514
Chrome plate & clear crystal
H: 400-1360 L: 670 W: 230mm
25W Int. LED 1500 lumens warm white
5. Verina 5lt Flush 76517
Chrome plate & clear glass
Proj: 150 Dia: 480mm 5 x G9

2. Verina Pendant 76513
Chrome plate & clear crystal H: 250-1360 Dia: 380mm
25W Int. LED 1500 lumens warm white
6. Verina Wall 76515
Chrome plate & clear crystal Proj: 80 H: 160 W: 160mm G9




3. Verina 12lt Pendant 76518
Chrome plate & clear glass H: 250-3000 Dia: 570mm 12 x G9
7. Verina Wall 76521
Chrome plate & clear glass Proj: 150 H: 135 W: 120mm G9
4. Verina 5lt Pendant 76520
Chrome plate & clear glass H: 250-1330 Dia: 420mm 5 x G9


















Effortless style for any interior space in various on trend finishes.












1.
3. Ortona 3lt Pendant 73411
Matt
5. Ortona Wall 70246












Modern styling for today’s interiors. An interior collection that mixes sophisticated metal finishes with a marble faux silk.



1. Studio 6lt Pendant 98136
Soft gold paint H: 300-822 Dia: 340mm
6 x E27
3. Studio Cable Set 80637
Matt black H: 220-1570 Dia: 100mm E27
5. Studio 5lt Semi Flush 98786
Satin brass plate Proj: 305 Dia: 530mm 5 x E27
2. Studio 6lt Pendant 81535
Matt black H: 300-822 Dia: 340mm
6 x E27
4. Studio 6lt Semi Flush 76502
Matt black Proj: 534 Dia: 553mm
6 x E27
6. Studio 5lt Semi Flush 79502
Matt
Proj: 305 Dia: 530mm 5 x E27






















1. Nixon 6lt Pendant 60179
Bright nickel plate & vintage white fabric
H: 300-790 Dia: 550mm 6 x E14
3. Nixon 3lt Pendant 60129
Bright nickel plate & vintage white fabric H: 300-790 Dia: 450mm 3 x E14
5. Nixon 2lt Wall 60180
Bright nickel plate & vintage white fabric
H: 180 H: 260 W: 350mm 2 x E14
7. Nixon 2lt Table 60804
Bright nickel plate & vintage white fabric
H: 540 Oval: 200-380mm 2 x E14
9. Nixon 2lt Floor 60803
Bright nickel plate & vintage white fabric H: 1570 Oval: 260-520mm 2 x E14
2. Nixon 6lt Pendant 70561
Brass plate & vintage white fabric
H: 300-790 Dia: 550mm
6 x E14
4. Nixon 3lt Pendant 70560
Brass plate & vintage white fabric
H: 300-790 Dia: 450mm
3 x E14
6. Nixon 2lt Wall 70562
Brass plate & vintage white fabric
H: 180 H: 260 W: 350mm 2 x E14
8. Nixon 2lt Table 70564
Brass plate & vintage white fabric H: 540 Oval: 200-380mm 2 x E14
10. Nixon 2lt Floor 70563
Brass plate & vintage white fabric H: 1570 Oval: 260-520mm 2 x E14


Adding that extra sparkle with premium crystal.





















1. Boyer 5lt Semi Flush
BOYER-5CH
Chrome plate & clear glass
Proj: 135 Dia: 410mm
5 x G9
3. Boyer 3lt Semi Flush
BOYER-3CH
Chrome plate & clear glass
Proj: 135 Dia: 400mm
3 x G9
5. Boyer 2lt Left Wall
BOYER-2WBCH-L
Chrome plate & clear glass
Proj: 95 H: 165 W: 215mm
2 x G9
2. Boyer 5lt Semi Flush
BOYER-5AB
Antique brass plate & clear glass
Proj: 135 Dia: 410mm
5 x G9
4. Boyer 3lt Semi Flush
BOYER-3AB
Antique brass plate & clear glass
Proj: 135 Dia: 400mm
3 x G9
6. Boyer 2lt Left Wall
BOYER-2WBAB-L
Antique brass plate & clear glass
Proj: 95 H: 165 W: 215mm
2 x G9












Chrome
Chrome plate & clear
Proj: 160 H: 140 W: 100mm

















1. Alton 5lt Pendant 1805-5SC
Satin chrome plate & opal glass
H: 310-635 Dia: 460mm
5 x E14
3. Alton 3lt Pendant 1805-3SC
Satin chrome plate & opal glass
H: 310-635 Dia: 460mm
3 x E14
5. Alton 2lt Wall 1805-2SC
Satin chrome plate & opal glass
Proj: 155 H: 190 W: 330mm
2 x E14
7. Alton Wall 1805-1SC
Satin chrome plate & opal glass
Proj: 185 H: 180 W: 125mm E14


2. Alton 5lt Pendant 1805-5AN
Antique brass plate & opal glass
H: 310-635 Dia: 460mm
5 x E14
4. Alton 3lt Pendant 1805-3AN
Antique brass plate & opal glass
H: 310-635 Dia: 460mm
3 x E14
6. Alton 2lt Wall 1805-2AN
Antique brass plate & opal glass
Proj: 155 H: 190 W: 330mm
2 x E14
8. Alton Wall 1 805-1AN
Antique brass plate & opal glass
Proj: 185 H: 180 W: 125mm E14









1. Bernice 5lt Pendant 2030-5AN
Antique brass plate
H: 510-660 Dia: 440mm
5 x E14
2. Bernice 5lt Pendant 2030-5AS
Antique silver effect finish
H: 510-660 Dia: 440mm
5 x E14
3. Bernice 3lt Pendant 2030-3AN
Antique brass plate
H: 510-650 Dia: 390mm
3 x E14
4. Bernice 3lt Pendant 2030-3AS
Antique silver effect finish
H: 510-650 Dia: 390mm
3 x E14
5. Bernice 2lt Wall 2030-2AN
Antique brass plate
Proj: 170 H: 180 W: 250mm
2 x E14















White painted glass shade with faint line pattern, available in satin chrome or antique brass plate.












A design classic perfect for adding an industrial touch to any home.





















1. Cagney 5lt Semi Flush CAGNEY-5SC
Satin chrome plate & white glass
Proj: 460 Dia: 640mm 5 x G9
3. Cagney 3lt Semi Flush CAGNEY-3SC
Satin chrome plate & white glass
Proj: 430 Dia: 550mm 3 x G9
5. Cagney Wall CAGNEY-1WBSC
Satin chrome plate & white glass
Proj: 260 H: 190 W: 205mm G9
2. Cagney 5lt Semi Flush CAGNEY-5AB
Antique brass plate & white glass
Proj: 460 Dia: 640mm 5 x G9
4. Cagney 3lt Semi Flush CAGNEY-3AB
Antique brass plate & white glass
Proj: 430 Dia: 550mm 3 x G9
6. Cagney Wall CAGNEY-1WBAB
Antique brass plate & white glass
Proj: 260 H: 190 W: 205mm G9




Bring a living space together with a wall and table lighting combination for a stylish modern look.









































in AUTUMN / WINTER 23


Clear cut faceted glass set amongst metal accents to create a gorgeous, sophisticated sparkle.






1. Clifton 5lt Pendant 104467
Bright nickel plate & clear crystal glass
H: 400-1720 Dia: 505mm
5 x E14
3. Clifton 5lt Pendant 106244
Antique brass plate & clear crystal glass
H: 400-1720 Dia: 505mm
5 x E14
2. Clifton 3lt Pendant 104466
Bright nickel plate & clear crystal glass
H: 400-1420 Dia: 385mm
3 x E14
4. Clifton 3lt Pendant 106243
Antique brass plate & clear crystal glass
H: 400-1420 Dia: 385mm
3 x E14










Suspended from matt black metalwork, perfect for creating a modern contemporary feel.












1. Lambeth Ribbed 4lt Pendant 106711
Antique brass plate & clear ribbed glass
H: 600-1980 Dia: 300mm 4 x E14
3. Lambeth 4lt Pendant 69455
Antique brass plate & clear glass
H: 600-1980 Dia: 300mm 4 x E14
5. Lambeth 4lt Pendant 70324
Satin nickel plate & clear glass H: 600-1980 Dia: 300mm 4 x E14



2. Lambeth Ribbed Pendant 106710
Antique brass plate & clear ribbed glass
H: 500-1900 Dia: 200mm E27
4. Lambeth Pendant 69454
Antique brass plate & clear glass
H: 500-1900 Dia: 200mm E27
6. Lambeth Pendant 70323
Satin nickel plate & clear glass
H: 500-1900 Dia: 200mm E27
















1. Hurst 3lt Pendant 95836
Matt antique brass plate & clear glass
H: 550-1430 W: 300 L: 950mm 3 x E27
5. Hurst Pendant 101541
Matt black & clear glass
H: 470-1600 Sq: 275mm E27
9. Darna Pendant 73569
Bright nickel plate & mercury glass
H: 600-1400 Dia: 300mm E27
13. Polperro Pendant 94371
Gloss cream & clear glass
H: 400-1515 Dia: 330mm E27
2. Hurst 3lt Pendant 76227
Bright nickel plate & clear glass
H: 550-1430 W: 300 L: 950mm 3 x E27
6. Hadden Pendant 76228
Bright nickel plate & clear glass
H: 550-1420 Sq: 215mm E27
10. Fenton Pendant 73103
Bright nickel plate & sandblasted glass
H: 700-1700 Dia: 370mm E27
3. Hurst Pendant 95835
Matt antique brass plate & clear glass H: 470-1440 Sq: 275mm E27
7. Storni Pendant EH-STORNI-L
Polished nickel plate & clear glass H: 640-1700 Dia: 285mm E27
11. Brampton Pendant 96178
Bright nickel plate & gloss white H: 500-1600 Dia: 368mm E27
4. Hurst Pendant 76225
Bright nickel plate & clear glass
H: 470-1440 Sq: 275mm E27
8. Storni Pendant EH-STORNI-S
Polished nickel plate & clear glass
H: 640-1700 Dia: 210mm E27
12. Crofton Pendant 96175
Bright nickel plate
H: 500-1490 Dia: 303mm E27





Reflective finishes of chrome, copper and bronze create stunning light reflections - perfect pendants for illuminating dining tables and living spaces.












1. Rock Pendant 97654
Chrome metallic glass & chrome plate
H: 420-1510 Dia: 300mm E27
2. Rock Pendant 97655
Copper metallic glass & chrome plate
H: 420-1510 Dia: 300mm E27
3. Rock Pendant 97656
Bronze metallic glass & chrome plate
H: 420-1510 Dia: 300mm E27
4. Rock 3lt Pendant 97657
Chrome metallic glass & chrome plate
H: 1010-1530 Dia: 420mm 3 x E27
5. Rock 3lt Pendant 97659
Copper metallic glass & chrome plate
H: 1010-1530 Dia: 420mm 3 x E27
6. Rock 3lt Pendant 97660
Bronze metallic glass & chrome plate H: 1010-1530 Dia: 420mm 3 x E27
7. Paloma Pendant 68958
Gold effect plate & clear ribbed glass
H: 400-1400 Dia: 250mm E14
8. Paloma Pendant 68959
Chrome plate & clear ribbed glass H: 400-1400 Dia: 250mm E14
9. Paloma Pendant 68956
Copper plate & clear ribbed glass
H: 400-1400 Dia: 250mm E14
10. Paloma 12lt Pendant 98115
Chrome plate with chrome, copper & gold glass
H: 560-2000 Dia: 490mm 12 x G9
11. Paloma 6lt Pendant 98113
Chrome plate with chrome, copper & gold glass
H: 1030-1200 Dia: 360mm 6 x G9
12. Esme 3lt Pendant 98152
Chrome plated with grey tinted, chrome & copper plated glass
H: 550-1900 Dia: 450mm 3 x E14










1. Viviana 15lt Pendant 72746
Chrome plate & champagne crystal glass
H: 800-2100 Dia: 720mm 15 x E14
4. Prisma 16lt Pendant 76486
Chrome plate & clear crystal
H: 1000-2000 Dia: 500mm
65W Int. LED 5246 lumens cool white
7. Celeste Ring Pendant 78702
Clear crystal glass & chrome plate
H: 350-1500 Dia: 620mm
28.5W Int. LED 2439 lumens cool white




2. Valetta 6lt Pendant 76430
Polished stainless steel & clear crystal glass H: 1000-1900 Dia: 670mm 6 x E14
5. Neve 3 Ring Pendant 76484
Chrome plate & clear crystal glass H: 190-1590 Dia: 745mm
95W Int. LED 6700 lumens warm white
8. Liliana Pendant 98150
Chrome plate & clear crystal glass H: 430-1800 Dia: 450mm
19.67W Int. LED 1251 lumens warm white



Maya 12lt Pendant 76436
Chrome plate & clear glass H: 500-1885 L: 1085 W: 355mm 12 x E14
6. Celeste 2 Ring Pendant 78701
Clear crystal glass & chrome plate H: 450-1500 Dia: 620mm 45W Int. LED 3460 lumens cool white











1. Adagio 9lt Pendant 96819-GO
Clear glass & gold effect plate
H: 700-2130 Dia: 550mm
9 x E14
2. Clarence 8lt Pendant 308-8CL
Clear acrylic & chrome plate
H: 785-2485mm Dia: 780mm
8 x E14
3. Clarence 12lt Pendant 308-8-4CL
Clear acrylic & chrome plate
H: 1030-2730mm Dia: 780mm 12 x E14
4. Amadis 6lt Pendant 96826-CH
Clear glass & chrome plate
H: 700-2100 Dia: 460mm
6 x E14
5. Celine 5lt Pendant 81913
Rose gold paint & clear glass
H: 680-1700 Dia: 450mm 5 x E14
6. Tanaro Pendant EH-TANARO-AB
Antique brass plate & clear glass
H: 375-1220 Dia: 300mm E27
7. Vienna 410mm Pendant 73108
Bright nickel plated brass & clear glass
H: 700-1480 Dia: 410mm E27
8. Vienna 305mm Pendant 73109
Bright nickel plated brass & clear glass
H: 750-1370 Dia: 305mm E27


The stunning details of these opulent pendants can be enjoyed when lit and unlit.
1. Loire 7lt pendant 76512
Bright nickel plate with fine chain
H: 1000-2100 Dia: 650mm
7 x E14
3. Orphelia 2lt Pendant 97219
Chrome plate & silver effect chain
H: 600-1820 L: 1180 D: 250mm
31.2W Int. LED 758 lumens warm white
5. Asha Pendant 93430
Polished nickel plate
H: 700-1710 Dia: 370mm E27
2. Loire 6lt pendant 76511
Bright nickel plate with fine chain
H: 850-1900 Dia: 500mm
6 x E14
4. Orphelia Oval Pendant 97214
Chrome plate & silver effect chain
H: 550-1830 L: 740 D: 220mm
26.36W Int. LED 579 lumens warm white
6. Paresh Pendant 93129
Polished nickel plate
H: 800-1770 Dia: 370mm E27















1. Minato Pendant 101675
3. Bali Pendant 101572
5. Stellan 6lt Linear Pendant 101684
2. Minato Pendant 101676
Natural bamboo & matt black H: 510-1200 Dia: 350mm E27
4. Bali Pendant 101574
Natural bamboo, white PC & matt black H: 450-1540 Dia: 420mm E27
6. Toba 4lt Pendant 73575
Add warmth and texture to living spaces with lighting designs made from natural bamboo, mango wood or oak stained plywood.






Stunning clear, iridescent or dark chromed glass shades create impressive pendants to complete a sophisticated designer look.
1. Utopia Pendant 94521
Clear glass & chrome plate
H: 600-1645 Dia: 320mm
E27
3. Infinity 6lt Pendant 76450
Chrome plate & iridescent glass
H: 600-1980 Dia: 650mm
6 x G9
5. Infinity 6lt Pendant 80199
Black chrome plate & dark chromed glass
H: 600-1980 Dia: 650mm
6 x G9



2. Lava Pendant 75664
Iridescent glass & chrome plate
H: 600-1645 Dia: 320mm
E27
4. Infinity Pendant 80123
Chrome plate & iridescent glass
H: 430-1500 Dia: 480mm
E27
6. Infinity 8lt Pendant 80124
Black chrome plate & dark chromed glass
H: 520-1290 W: 720 D: 500mm
8 x G9













1. Edrea 4lt Pendant 81914
Satin brass plate & frosted glass
H: 620-1000 Dia: 480mm
4 x E14
2. Lainey 4lt Pendant 81916
Antique brass plate & clear crystal
H: 600-1000 Dia: 480mm
4 x E14
3. Garland 4lt Pendant 81915
Polished nickel plate & clear crystal
H: 630-1200 Dia: 580mm
4 x E14
4. Whistle 6lt Pendant WHISTLE-6NI
Nickel plate
H: 903-1815 Dia: 650mm
6 x E14
5. Ritz 6lt Pendant 81508
Bright nickel plate with clear crystal & faceted acrylic
H: 600-1200 Dia: 500mm
6 x E14
6. Ritz 3lt Pendant 81507
Bright nickel plate with clear crystal & faceted acrylic
H: 550-1200 Dia: 425mm
3 x E14










1. Kimberley Pendant 99498
Gold paint finish H: 350-1550 Dia: 310mm E27
3. Nicola Pendant 68986 Antique copper plate H: 350-1300 Dia: 300mm E27
5. Armour Pendant 72817
Chrome plate
H: 450-1350 Dia: 320mm E27
7. Deco Pendant 76686
Matt black & satin gold paint H: 570-1490 Dia: 400mm E27
9. Sirolo 3lt Pendant 81750 Antique brushed bronze paint H: 400-1160 Dia: 480mm 3 x E14
2. Kimberley Pendant 72813
Copper plate
H: 350-1550 Dia: 310mm E27
4. Nicola Pendant 68987
Antique copper plate H: 450-1400 Dia: 300mm E27
6. Armour Pendant 72815
Copper plate
H: 450-1350 Dia: 320mm E27
8. Jaxon 6lt Pendant 98151
Matt black & gold effect plate H: 1000-1360 Dia: 300mm 6 x E14
10. Sirolo 5lt Pendant 81752
Antique brushed bronze paint H: 500-1230 Dia: 600mm 5 x E14














1. Morad Pendant 69783
Aged brass plate
H: 750-2000 Dia: 620mm
E27
2. Clooney 8lt Pendant 61294
Slate grey & smoked cut glass
H: 500-1220 Dia: 500mm
8 x E14
3. Clooney 4lt Pendant 61281
Slate grey & smoked cut glass
H: 500-1220 Dia: 350mm
4 x E14
4. Chevalier 12lt Pendant 61026
Aged metal paint
H: 700-1710 Dia: 700mm
12 x E14
5. Miele 3lt Pendant 73560
Antique brass plate & clear glass
H: 600-2005 Dia: 470mm
3 x E14
6. Miele Pendant 69784
Antique brass plate & clear glass
H: 600-1860m Dia: 370mm E27
7. Avery Pendant 73117
Antique brass plate & clear glass
H: 800-1650 Dia: 230mm E27
8. Brydon Pendant 71124
Clear ribbed glass & antique brass plate
H: 600-1000 Dia: 350mm E27
9. Ebbe Pendant 95462
Antique gold paint & clear glass
H: 425-1320 H: 280 Dia: 218mm E27









Fully height adjustable cluster pendants that create the perfect dining room centrepiece or dramatic stairwell lighting.




Harbour
Use with or without facet glass detail


1. April 6lt Pendant 99593
Chrome plate, clear & multi coloured glass
H: 1200-1640 Dia: 480mm
6 x G9
3. Niro 10lt Pendant NIRO-10MULTI
Multi coloured glass & chrome plate
H: 440-1220 Dia: 395mm
10 x G4 (Halogen only)
2. April 3lt Pendant 99786
Chrome plate, clear & multi coloured glass
H: 820-1620 Dia: 400mm
3 x G9
4. Harbour 7lt Pendant 76292
Chrome plate & clear glass with bubbles
H: 315-1440 Dia: 500mm
7 x E14




1. Cosma 5lt Linear Pendant 97624
Textured black & white silicone
H: 400-1750 L: 1165 D: 165mm
70W Int. LED 2310 lumens warm white
5. Staten Pendant 80628
Matt black & white silicone
H: 200-1500 Dia: 800mm
43.5W Int. LED 1800 lumens warm white
9. Kline 3 Ring Pendant KLINE-3CH
Chrome plate & frosted acrylic
H: 480-1250 Dia: 600mm
41W Int. LED 2450 lumens warm white
13 Attalea Linear Pendant 97629
Satin gold paint & white silicone
H: 450-1740 L: 1200 D: 200mm
43.7W Int. LED 4000 lumens warm white
17. Synergy Pendant 90322
Textured coffee paint & white silicone
H: 600-1365 Dia: 630mm
41W Int. LED 2500 lumens warm white
2. Cosma 8lt Pendant 97625
Textured black & white silicone
H: 1700-2000 Dia: 575mm
109W Int. LED 3500 lumens warm white
6. Staten Pendant 80629
Matt white & white silicone
H: 200-1500 Dia: 800mm
43.5W Int. LED 2000 lumens warm white
10. Kline 2 Ring Pendant KLINE-2CH
Chrome plate & frosted acrylic
H: 480-1250 Dia: 450mm
28W Int. LED 1400 lumens warm white
14. Attalea Pendant 97631
Satin gold paint & white silicone
H: 500-1750 Dia: 740mm
43.7W Int. LED 4000 lumens warm white
18. Synergy Pendant 81893
Textured white paint & white silicone
H: 600-1200 Dia: 630mm
41W Int. LED 2900 lumens warm white
3. Cosma 3lt Pendant 97623
Textured black & white silicone
H: 800-1455 Dia: 415mm
42.5W Int. LED 1380 lumens warm white
7. Staten Pendant 97606
Textured black & white silicone
H: 350-1700 Dia: 600mm
42W Int. LED 1750 lumens warm white
11. Rafe Pendant 90323
Matt brushed gold effect & white silicone
H: 300-1200 Dia: 570mm
36.5W Int. LED 1800 lumens warm white
15. Ozias 5lt Pendant 81906
Chrome plate & clear crystal detail
H: 800-1500 Dia: 750mm
97W Int. LED 5200 lumens warm white
19. Paradox Pendant 80683
Matt white paint & white acrylic
H: 250-1300 W: 600 D: 250mm
29.5W Int. LED 1987 lumens warm white
4. Gen Pendant 80572
Matt nickel plate & frosted acrylic
H: 600-1200 Dia: 600mm
42W Int. LED 2450 lumens warm white
8. Scribble Ring Pendant 72479
Gold leaf & frosted acrylic
H: 480-1700 Dia: 550mm
31.5W Int. LED 1400 lumens warm white
12. Rafe Pendant 81903
Satin nickel plate & white silicone
H: 300-1200 Dia: 570mm
36.5W Int. LED 1800 lumens warm white
16. Ozias 3lt Pendant 90292
Chrome plate & clear crystal detail
H: 600-1200 Dia: 550mm
49.5W Int. LED 2400 lumens warm white

























2. Kora 5lt Pendant KORA-5AB
1. Kora 8lt Pendant KORA-8AB
Antique brass plate
H: 645-1200 Dia: 885mm
8 x E14
5. Parkstone 8lt Pendant 2013-8CH
Chrome plate & clear glass
H: 400-720 Dia: 560mm
8 x E14
9. Ayres 6lt Semi Flush AYRES-6CH
Chrome plate & scavo glass
Proj: 555 Dia: 665mm
6 x G9
Antique brass plate H: 465-1085 Dia: 610mm 5 x E14
6. Parkstone 5lt Pendant 2013-5CH
Chrome plate & clear glass H: 400-720 Dia: 440mm 5 x E14
10. Ayres 4lt Semi Flush AYRES-4CH
Chrome plate & scavo glass
Proj: 515 Dia: 585mm 4 x G9




3. Kora 8lt Pendant KORA-8CH
Chrome plate H: 645-1200 Dia: 885mm 8 x E14
7. Astaire 8lt Pendant ASTAIRE-8SN
Satin nickel plate & natural fabric H: 465-1520 Dia: 750mm 8 x E14
11. Lullaby 5lt Pendant LULLABY-5CR
Cream/br gold paint & clear/pearl acrylic H: 526-1150 Dia: 505mm 5 x E14




4. Phantom 7lt Pendant PHANTOM-7CH
Chrome plate & white fabric H: 450-895 Dia: 544mm
7 x E14
8. Astaire 5lt Pendant ASTAIRE-5SN
Satin nickel plate & natural fabric
H: 465-1520 Dia: 710mm
5 x E14
12. Lullaby 3lt Pendant LULLABY-3CR
Cream/br gold paint & clear/pearl acrylic H: 475-1100 Dia: 370mm
3 x E14


Kora 5lt Pendant KORA-5CH
Chrome plate
H: 465-1085 Dia: 610mm
5 x E14














1. Connery Pendant 61320
Matt nickel plate H: 400-1725 Dia: 330mm E27
3. Brosnan Pendant 61299 Matt antique brass paint H: 300-1900 Dia: 300mm 19W Int. LED 1500 lumens cool white
5. Colman Pendant COLMAN-BL Matt black & gold leaf H: 290-850 Dia: 345mm E27
7. Polka Rise & Fall Pendant POLKA-AB Antique brass plate H: 920-1980 Dia: 370mm E27
9. Willis Pendant 60182 Tinted cognac & copper glass H: 300-1284 Dia: 246mm E27
2. Connery Pendant 64567
Matt bronze paint H: 400-1725 Dia: 330mm E27
4. Brosnan Pendant 61296
Matt nickel plate H: 300-1900 Dia: 300mm 19W Int. LED 1500 lumens cool white
6. Hansen Pendant 76713
Bright nickel plate & clear ribbed glass H: 400-1200 Dia: 302mm E27
8. Polka Rise & Fall Pendant POLKA-SN Satin nickel plate H: 920-1980 Dia: 370mm E27






1.
Copper plate
H: 220-1620 Dia: 150-3000mm 6 x E27
2.
Chrome plate
H: 220-1620 Dia: 150-3000mm 6 x E27
H: 220-1620 Dia: 150-3000mm 6

Chrome plate
H: 220-1620 Dia: 150-3000mm 3 x E27







1. Urban Pendant 76587 Antique brass plate
H: 220-1620 Dia: 100mm E27
5. Studio Pendant 76581 Matt black H: 220-1620 Dia: 100mm E27


2. Urban Pendant 76586 Black chrome plate H: 220-1620 Dia: 100mm E27
6. Cable Set Flex 61809 Antique brass plate H: 150-1600 Dia: 120mm E27


3. Studio Pendant 76578
plate H: 220-1620 Dia: 100mm E27
7. Cable Set Flex 61807 Chrome plate H: 150-1600 Dia: 100mm E27


4. Studio Pendant 76573
plate H: 220-1620 Dia: 100mm E27
8. Studio Cable Set 80637 Matt black H: 220-1570 Dia: 100mm E27





































Combine with a cable set to create a fitting perfect for your interior needs.








1. Stockheld Pendant Shade 73287
Antique solid brass & clear glass
H: 200 Dia: 170mm E27 or B22
3. Beaumont Pendant Shade 60892
Clear glass & antique brass plate
H: 240 Sq: 155mm E27 or B22
5. Dimitri Pendant Shade 73976
Grey glass with bubbles
H: 200 Dia: 300mm E27 or B22
7. Plexus Pendant Shade 72831
Black & antique brass plate
H: 300 Dia: 340mm E27 or B22
2. Ripley Pendant Shade 73296
Antique solid brass & clear/smoked glass
H: 235 Dia: 190mm E27 or B22
4. Elstow Pendant Shade 60874
Clear glass & chrome plate
H: 250 Dia: 220mm E27 or B22
6. Dimitri Pendant Shade 73974
Clear glass with bubbles
H: 200 Dia: 300mm E27 or B22
8. Plexus Pendant Shade 72829
Black & antique brass plate
H: 210 Dia: 250mm E27 or B22












































1. Maye 6lt Semi Flush 97232
Chrome plate & white confetti glass
Proj: 180 Dia: 600mm 6 x G9
5. Delos 3lt Semi Flush 96641
Chrome plate & white confetti glass
Proj: 180 Dia: 600mm 3 x G9 2. Maye 6lt Semi Flush 97233
brass plate & white confetti glass Proj: 180 Dia: 600mm
x G9
6. Delos 3lt Semi Flush 97647
Antique brass plate & white confetti glass Proj: 180 Dia: 600mm 3 x G9 3. Maye 3lt Semi Flush 97230 Chrome plate & white confetti glass Proj: 160 Dia: 475mm 3 x G9


Maye 3lt Semi Flush 97231
brass plate & white confetti glass Proj: 160 Dia: 475mm
x G9


1. Amari 3lt Semi Flush 96833
Chrome plate & clear glass
Proj: 120 Dia: 565mm
3 x E14
3.
5lt Semi Flush 95291
5. Ellipse 3lt Semi Flush 95289
2. Amari 3lt Semi Flush 97228
Polished brass plate & clear glass
Proj: 120 Dia: 565mm
3 x E14
4.
3lt Semi Flush 97234
6. Ellipse 3lt Semi Flush 95290
Chrome plate with pink, champagne & grey tinted glass
Proj: 188mm 3 x G9




















1. Melody 6lt Flush 81955
Chrome plate & clear crystal
Proj: 485 Dia: 480mm
6 x G9
5. Auria 6lt Semi Flush 76349
Chrome plate & clear glass with beaded wire
Proj: 300 Dia: 710mm
6 x G9
9. Aherne 5lt Semi Flush AHERNE-5CH
Chrome plate with clear glass & chrome wire
Proj: 85 Dia: 472mm
5 x G9
2. Siena 5lt Flush 61564
Chrome plate & clear crystal
Proj: 285 Dia: 445mm 5 x G9
6. Auria 3lt Semi Flush 76880
Chrome plate & clear glass with beaded wire
Proj: 130 Dia: 460mm 3 x G9
10. Aherne 5lt Semi Flush 73757
Antique brass plate with clear glass & brass wire
Proj: 85 Dia: 472mm 5 x G9
3. Motown 4lt Flush MOTOWN-4CH
Chrome plate & clear crystal
Proj: 165 Dia: 300mm 4 x G9
7. Alda 5lt Semi Flush ALDA-5CH
Chrome plate & clear glass
Proj: 310 Dia: 485mm 5 x E14
11. Aherne 3lt Semi Flush 73758
Antique brass plate with clear glass & brass wire
Proj: 85 Dia: 430mm 3 x G9
Crystal details and curving arms create interest and character.
4. Swayze Flush 61340
Chrome plate & clear acrylic
Proj: 100 Dia: 400mm
15.98W Int. LED 1183 lumens warm white
8. Alda 3lt Semi Flush A LDA-3CH
Chrome plate & clear glass
Proj: 310 Dia: 400mm 3 x E14










1. Brahm 2lt Flush 91123
Antique brass plate & frosted glass
Proj: 100 Dia: 320mm 2 x E14
5. Hampworth 3lt Flush 96153
Bright nickel plate & clear glass
Proj: 305 Dia: 357mm 3 x E14
9. Haughton 3lt Semi Flush 601-3AN
Antique brass plate & opal glass
Proj: 335 Dia: 385mm 3 x E14
13. Avali 3lt Semi Flush 80682
Matt black & white acrylic
Proj: 367 W: 392 D: 292mm
24.12W Int. LED 1950 lumens warm white









2. Atlas 2lt Flush 91121
Antique brass plate & frosted glass
Proj: 100 Dia: 430mm 2 x E27
6. Barford Semi Flush 96182
Bright nickel plate & clear glass
Proj: 232 Dia: 320mm E27
10. Addington Semi Flush 97684
Antique brass plate & clear ribbed glass
Proj: 350 Dia: 200mm E27
14. Avali 3lt Semi Flush 81036
Chrome plate & white acrylic
Proj: 367 W: 392 D: 292mm 24.36W Int. LED 1950 lumens warm white

3. Roundel 2lt Flush 633-32
Frosted/clear glass & chrome plate
Proj: 95 Dia: 320mm 2 x E14
7. Barford Semi Flush 96183
Bright nickel plate & gloss opal glass
Proj: 232 Dia: 320mm E27
11. Addington Semi Flush 96169
Bright nickel plate & clear ribbed glass
Proj: 350 Dia: 200mm E27
15. Harper LED 2lt Medium Flush 81691
Chrome plate & opal glass
Proj: 139 L: 1278 W: 87mm 2 x 16W T5 incl. 3372 lumens daylight white


4. Firenz Semi Flush 387-30SC
Satin chrome plate & clear/frosted glass
Proj: 180 Dia: 300mm R7s
8. Darton Semi Flush 96181
Bright nickel plate
Proj: 230 Dia: 310mm E27
12. Clef 3lt Bar Semi Flush CLEF-BAR-3CH
Chrome plate & white glass H: 510-750 L: 970 W: 115mm 3 x G9
16. Harper LED 2lt Small Flush 81693
Chrome plate & opal glass
Proj: 132 L: 679 W: 87mm 2 x 8W T5 incl. 1664 lumens daylight white








































1. Piccolo Wall 96751-CH
Chrome plate & white fabric
Proj: 180 H: 255 W: 265mm E27
5. Meadow 2lt Wall 2007-2WBCH
Chrome plate & white glass
Proj: 205 H: 200 W: 310mm
2 x E14
9. Marconi 2lt Wall MARCONI-2WBLI
Mosaic glass & satin nickel plate
Proj: 80 H: 385 W: 200mm
2 x E14

2. Piccolo Wall 61604
Satin nickel plate & white fabric
Proj: 180 H: 255 W: 265mm E27
6. Domina 2lt Wall DOMINA-2WBNI
Nickel plate & white fabric
Proj: 220 H: 370 W: 360mm 2 x E14
10. Marconi 2lt Wall MARCONI-2WBCH
Mosaic mirror glass & satin nickel plate
Proj: 80 H: 385 W: 200mm 2 x E14






11. Quay Flush/Wall
in AUTUMN / WINTER 23 IP44 rated
3. Obi Wall 70334 Vintage white linen
Proj: 140 H: 180 W: 315mm E27
7. Domina Wall DOMINA-1WBNI
Nickel plate & white fabric
Proj: 240 H: 370 W: 130mm E14
11. Quay Flush/Wall 93995
Gloss black glaze & chrome plate
Proj: 80mm Dia: 160mm E27

4. Obi Wall 70335
Natural linen
Proj: 140 H: 180 W: 315mm E27
8. Elms Wall 73104
Antique solid brass
Proj: 185 H: 205 W: 130mm E27






1. Hillside Wall UG-WB-G
Unglazed ceramic Proj: 150 H: 100 W: 310mm E27
5. Blake Wall 143-WB
Clear/frosted glass & chrome plate
Proj: 60 H: 255 W: 235mm E14


2. Eton Wall UG-WB-X Unglazed ceramic Proj: 130 H: 120 W: 265mm E27
6. Bodhi 285 Wall 70118
Textured matt white Proj: 50 H: 80 W: 285mm 12W Int. LED 940 lumens warm white

3. Pride Wall UG-WB-A
ceramic
130 H: 135 W: 265mm E27
7. Jenkins Wall 61031
Polished aluminium & white paint Proj: 115m H: 140 W: 265mm 7.84W Int. LED 700 lumens warm white

















2. Turner 2lt 355mm Wall
1. Turner 230mm Wall
PL200-E14-SWAN
Antique brass plate
Proj: 160 H: 185 W: 230mm E14
5. Linton 2lt Wall
PL-LEDG9-SC
Satin chrome plate
Proj: 150 H: 175 W: 280mm 2 x G9
PL350-E14-SWAN
Antique brass plate
Proj: 160 H: 185 W: 355mm 2 x E14
6. Linton 2lt Wall
PL-LEDG9-AN
Antique brass plate
Proj: 150 H: 175 W: 280mm 2 x G9
3. Turner 2lt 355mm Wall
PL350-E14-SWCH
Chrome plate
Proj: 160 H: 185 W: 355mm 2 x E14
4. Turner 2lt 355mm Wall
PL350-E14-SWBP
Brass plate
Proj: 160 H: 185 W: 355mm 2 x E14
























1. Rennes Wall Fitting 97872
Antique brass plate
Proj: 170 H: 350 W: 150mm E14
5. Rennes & Cici 103355
Antique brass plate & ivory linen mix fabric
Proj: 270 H: 475 W: 205mm E14
9. Rennes & Cici 103359
Bright nickel plate & grey linen mix fabric
Proj: 270 H: 475 W: 205mm E14
13. Rouen & Chatsworth 103361
Antique brass plate & ivory silk
Proj: 345 H: 460 W: 255mm E27
17. Rouen & Cici 103363
Bright nickel plate & ivory linen mix fabric
Proj: 325 H: 425 W: 205mm E27

2. Rennes Wall Fitting 97877
Bright nickel plate
Proj: 170 H: 350 W: 150mm E14
6. Rennes & Carla 103356
Bright nickel plate & cream fabric
Proj: 290 H: 520 W: 260mm E14
10. Rouen Wall Fitting 97875
Antique brass plate
Proj: 225 H: 330 W: 120mm E27
14. Rouen & Cici 103362
Antique brass plate & ivory linen mix fabric
Proj: 325 H: 425 W: 205mm E27
18. Rouen & Cici 103367
Bright nickel plate & grey linen mix fabric
Proj: 325 H: 425 W: 205mm E27
3. Rennes & Carla 103346
Antique brass plate & cream fabric
Proj: 290 H: 520 W: 260mm E14
7. Rennes & Chatsworth 103357
Bright nickel plate & ivory silk
Proj: 295 H: 500 W: 255mm E14
11. Rouen Wall Fitting 97880
Bright nickel plate
Proj: 225 H: 330 W: 120mm E27
15. Rouen & Carla Wall 103364
Bright nickel plate & cream fabric
Proj: 345 H: 490 W: 260mm E27
4. Rennes & Chatsworth 103354
Antique brass plate & ivory silk
Proj: 295 H: 500 W: 255mm E14
8. Rennes & Cici 103358
Bright nickel plate & ivory linen mix fabric
Proj: 270 H: 475 W: 205mm E14
12. Rouen & Carla 103360
Antique brass plate & cream fabric
Proj: 345 H: 490 W: 260mm E27
16. Rouen & Chatsworth 103366
Bright nickel plate & ivory silk
Proj: 345 H: 460 W: 255mm E27



































Add character and charm to your interior with these high quality detailed resin figurine table lights
Exceptional detail from every ear to paw.














1. Capuchin Table 106791
Matt black
H: 375 W: 135 D: 395mm E27
2. Capuchin Table 106792
Vintage gold paint & matt black
H: 375 W: 135 D: 395mm E27
3. Barack Bear Table 106787
Matt black & black fabric
H: 445 W: 505 D: 260mm E27
4. Barack Bear Table 106788
Vintage silver paint & black fabric
H: 445 W: 505 D: 260mm E27
5. Westie Table 106794
Matt black & natural linen
H: 430 W: 220 D: 220mm E14
6. Fox Table 106796
Vintage gold paint & black fabric
H: 530 Dia: 300mm E14



1. Zeus Table 93866
Black marble & gloss opal glass
H: 184 W: 230 D: 150mm E14
5. Quay Table 93997
Gloss black glaze & chrome plate
Proj: 100mm Dia: 160mm E27

2. Contour Table 93868
Gloss black glaze & matt opal glass H: 148 W: 220 D: 120mm G9
6. Quay Table 93996
Gloss white glaze & chrome plate
Proj: 100mm Dia: 160mm E27



3. Pax Table 90418
Matt antique copper, pewter plate and gloss opal glass H: 170 Dia: 120mm G9



4. Aurelio Table Small 97373
Matt black H: 223 W: 230 D: 132mm 4w Int. LED 18 lumens warm white













1. Annabelle Table Base

4. Annabelle & Freya Table

7. Annabelle & Freya Table







1. Annabelle Table Base 93003
Frosted crystal & brushed gold plated finish H: 445 Dia: 110mm E14
2. Annabelle & Mia Table 98339
Frosted crystal & vintage white linen H: 655 Dia: 350mm E14
3. Annabelle & Mia Table 98341
Frosted crystal & natural linen H: 655 Dia: 350mm E14
4. Annabelle & Freya Table 98342
Frosted crystal & charcoal grey silk H: 630 Dia: 355mm E14
5. Annabelle & Freya Table 98344
Frosted crystal & dusky pink silk H: 630 Dia: 355mm E14
6. Annabelle & Freya Table 98345
Frosted crystal & oyster silk H: 630 Dia: 355mm E14
7. Annabelle & Freya Table 98346
Frosted crystal & fir silk H: 630 Dia: 355mm E14
8. Annabelle & Cici Table 98349
Frosted crystal & grey linen mix fabric H: 630 Dia: 355mm E14
9. Annabelle & Cici Table 98350 Frosted crystal & ivory linen mix fabric H: 630 Dia: 355mm E14








1. Westcombe 2lt Table 98086
Ribbed bubble glass & vintage white fabric
H: 445 Dia: 355mm E27 & E14
5. Dinton Table Base 94367
Bright nickel plate & clear glass
H: 370 Dia: 176mm E27
9. Naia Table 93115
Rose pink ribbed glass, antique brass plate & mocha velvet
H: 650 Dia: 315mm E27
13. Avebury Table Base 94350
Antique brass plate & clear glass
H: 515 Sq: 110mm E27

2. Knighton 2lt Table 98085
Clear textured glass & vintage white fabric H: 462 Dia: 355mm E27 & E14
6. Wistow Table Base 73106
Solid brass & clear glass H: 450 Dia: 160mm E27
10. Naia Table 93424
Charcoal ribbed glass, bright nickel plate & mocha velvet H: 650 Dia: 315mm E27
14. Avebury Table Base 94358
Antique chrome plate & clear glass H: 515 Sq: 110mm E27




3. Gideon Table 90559
Clear glass & antique brass plate with black fabric
H: 595 Dia: 350mm E27
7. Wistow & Mia Table 91213
Solid brass, clear glass & vintage white linen H: 675 Dia: 350mm E27
11. Naia Table 93114
Teal ribbed glass, antique brass effect plate & mocha velvet
H: 650 Dia: 315mm E27
15. Verdone Table VERDONE
Clear crystal & taupe silk H: 785 Dia: 410mm E27



4. Gideon Table 90535
Clear glass & nickel plate with white linen fabric
H: 595 Dia: 350mm E27
8. Wistow & Mia Table 91215
Solid brass, clear glass & natural linen
H: 675 Dia: 350mm E27
12. Murford Table 96940-TLCH
Chrome plate & clear acrylic with white fabric
H: 435 Sq: 200mm E14




Light up corners of the home with sculptural glass based table lights.














Table lighting that adds a luxurious and glamorous touch to any space


1. Calan Table 93137
Gold effect plate & black cotton fabric
H: 600 Dia: 360mm E27
5. Kew Table KEW-TLGO
Gold tinted glass & mink fabric
H: 585 Oval: 200-400mm E27


2. Dahlia Table 95461
Capiz detail, ant. brass plate & ivory fabric
H: 640 Dia: 340mm E27
6. Dalston Table Base DALSTON-TLAB
Cream crackle glaze & ant. brass plate
H: 310 Dia: 140mm E14



3. Samuel Table 90588
Vintage white linen & volcano ombre foil
H: 640 Dia: 410mm E27
7. Vilana Table VILANA-TLGO
Antique gold leaf, black marble with black fabric
H: 780 Oval: 260-460mm E27


4. Meteora Table 90589
Vintage white linen & pearl ombre foil
H: 655 Dia: 410mm E27
8. Hiero Task Table 93140
Antique solid brass
H: 550 W: 360 D: 112mm E14









Luxurious gloss blue grey glazed base with soft curves and edges.
1. Provence Table Base 100166
Blue grey glaze & satin nickel plate
H: 445 Dia: 165mm E27
3. Provence & Carla 103379
Blue grey glaze, satin nickel plate & cream fabric
H: 650 Dia: 410mm E27
5. Provence & Cici 103376
Blue grey glaze, satin nickel plate & ivory linen mix fabric
H: 685 Dia: 455mm E27
7. Provence & Cici 103377
Blue grey glaze, satin nickel plate & grey linen mix fabric
H: 685 Dia: 455mm E27
2. Provence & Chatsworth 103378
Blue grey glaze, satin nickel plate & ivory silk fabric
H: 660 Dia: 405mm E27
4. Provence & Carla 103380
Blue grey glaze, satin nickel plate & cream fabric
H: 675 Dia: 460mm E27
6. Provence & Cici 103369
Blue grey glaze, satin nickel plate & ivory linen mix fabric
H: 660 Dia: 405mm E27
8. Provence & Cici 103375
Blue grey glaze, satin nickel plate & grey linen mix fabric
H: 660 Dia: 405mm E27




1. Ilsa Table 79842
Grey black painted glass & matt nickel plate with mink fabric
H: 590 Dia: 400mm E27
5. Portal Table 0195-DW
Dark wood & cream fabric
H: 590 Sh Rect: 180-365mm E27



2. Joss Table Base 90566
Dark grey wash wood
H: 502 Dia: 178mm E27
6. Mrs Table Base 96105
Matt white ceramic & brushed chrome plate
H: 260 Dia: 210mm E27


3. Marsham Table MARSHAM-TLIV
Ivory painted wood & ivory fabric
H: 480 Dia: 280mm E14
7. Mrs & Cici Table 98387
Matt white ceramic & grey linen mix fabric
H: 445 Dia: 310mm E27


4. Marsham Table MARSHAM-TLTA
Taupe painted wood & ivory fabric
H: 480 Dia: 280mm E14
8. Mrs & Cici Table 98388
Matt white ceramic & ivory linen mix fabric
H: 445 Dia: 310mm E27

1. Jemma Table Base 82114
Smokey grey ribbed glass & satin nickel plate
H: 340 Dia: 250mm E27
4. Jemma & Evie Navy Shade 92906
Smokey grey ribbed glass & navy cotton H: 545 Dia: 355mm E27
8. Jemma & Evie Navy Shade 92888
Clear ribbed glass & navy cotton H: 545 Dia: 355mm E27
12. Jemma & Evie Navy Shade 92897
Dusky pink ribbed glass & navy cotton H: 545 Dia: 355mm E27


2. Jemma Table Base 81896
Clear ribbed glass & satin nickel plate H: 340 Dia: 250mm E27
5. Jemma & Evie Yellow Shade 92907
Smokey grey ribbed glass & yellow cotton
H: 545 Dia: 355mm E27
9. Jemma & Evie Yellow Shade 92889
Clear ribbed glass & yellow cotton
H: 545 Dia: 355mm E27
13. Jemma & Evie Yellow Shade 92898
Dusky pink ribbed glass & yellow cotton H: 545 Dia: 355mm E27





8.



3. Jemma Table Base 81909
Dusky pink ribbed glass & satin nickel plate H: 340 Dia: 250mm E27
6. Jemma & Mia Vintage White Shade 92908
Smokey grey ribbed glass & vintage white linen H: 570 Dia: 350mm E27
10. Jemma & Mia Vintage White Shade 92890
Clear ribbed glass & vintage white linen H: 570 Dia: 350mm E27
14. Jemma & Mia Vintage White Shade 92899
Dusky pink ribbed glass & vintage white linen H: 570 Dia: 350mm E27
7. Jemma & Mia Natural Shade 92910
Smokey grey ribbed glass & natural linen
H: 570 Dia: 350mm E27
11. Jemma & Mia Natural Shade 92892
Clear ribbed glass & natural linen
H: 570 Dia: 350mm E27
15. Jemma & Mia Natural Shade 92901
Dusky pink ribbed glass & natural linen
H: 570 Dia: 350mm E27












1. Adelie & Freya Charcoal Shade 98351
Clear crystal glass & charcoal silk
H: 575 Dia: 305mm E14
5. Adelie & Freya Fir Shade
98358
Clear crystal glass & fir silk
H: 575 Dia: 305mm E14
9. Adelie & Freya Charcoal Shade 100353
Blush crystal glass & charcoal grey silk
H: 575 Dia: 305mm E14
13. Adelie & Freya Fir Shade 100357
Blush crystal glass & fir silk
H: 575 Dia: 305mm E14

2. Adelie & Freya Silver Shade
98352
Clear crystal glass & silver silk
H: 575 Dia: 305mm E14
6. Adelie & Cici Grey Shade
98360
Clear crystal glass & grey fabric
H: 590 Dia: 310mm E14
10. Adelie & Freya Silver Shade 100354
Blush crystal glass & silver satin silk
H: 575 Dia: 305mm E14
14. Adelie & Cici Grey Shade 100359
Blush crystal glass & grey fabric
H: 590 Dia: 310mm E14





& Freya Silver


14. Adelie & Cici Grey Shade
3. Adelie & Freya Dusky Shade 98353
Clear crystal glass & dusky pink silk
H: 575 Dia: 305mm E14
7. Adelie & Cici Ivory Shade 98361
Clear crystal glass & ivory fabric
H: 590 Dia: 310mm E14
11. Adelie & Freya Dusky Shade 100355
Blush crystal glass & dusky pink silk
H: 575 Dia: 305mm E14
15. Adelie & Cici Ivory Shade 100360
Blush crystal glass & ivory fabric
H: 590 Dia: 310mm E14

4. Adelie & Freya Oyster Shade 98357
Clear crystal glass & oyster silk
H: 575 Dia: 305mm E14
8. Adelie & Wentworth Blue Shade 98377
Clear crystal glass & midnight blue silk
H: 595 Dia: 305mm E14
12. Adelie & Freya Oyster Shade 100356
Blush crystal glass & oyster silk
H: 575 Dia: 305mm E14
16. Adelie & Wentworth Blue Shade 100363
Blush crystal glass & midnight blue silk
H: 595 Dia: 305mm E14










1. Adelie Table Base 93005
Clear crystal glass & bright nickel plate
H: 430 Sq: 110mm E14
4. Adelie & Freya Charcoal Shade
100341
Grey green tinted crystal glass & charcoal grey silk H: 575 Dia: 305mm E14
8. Adelie & Freya Fir Shade
100345
Grey green tinted crystal glass & fir silk H: 575 Dia: 305mm E14


2. Adelie Table Base 98106
Blush crystal glass & bright nickel plate H: 430 Sq: 110mm E14
5. Adelie & Freya Silver Shade 100342
Grey green tinted crystal glass & silver satin silk H: 575 Dia: 305mm E14
9. Adelie & Cici Grey Shade 100347
Grey green tinted crystal glass & grey fabric H: 590 Dia: 310mm E14





3. Adelie Table Base 98067
Grey green tinted crystal glass & bright nickel plate H: 430 Sq: 110mm E14
6. Adelie & Freya Dusky Shade 100343
Grey green tinted crystal glass & dusky pink silk H: 575 Dia: 305mm E14
10. Adelie & Cici Ivory Shade 100348
Grey green tinted crystal glass & ivory fabric H: 590 Dia: 310mm E14

7. Adelie & Freya Oyster Shade
100344
Grey green tinted crystal glass & oyster silk H: 575 Dia: 305mm E14
11. Adelie & Wentworth Blue Shade 100351
Grey green tinted crystal glass & midnight blue silk H: 595 Dia: 305mm E14







1. Artichoke Table 99147
Oatmeal crackle glaze & antique brass plate
H: 100 Dia: 150mm
E27
5. Saroma Table 98495
Matt myrtle green paint
H: 410 Dia: 180mm E14
9. Shape Rectangle Table 92224
Matt black
H: 295 W: 282 D: 150mm E27





2. Terrazzo Table 78181
White terrazzo
H: 130 Dia: 100mm
E27
6. Saroma Table 98494
Matt black paint
H: 410 Dia: 180mm E14
10. Shape Circle Table 92222
Matt black
H: 312 W: 312 D: 140mm E27


3. Terrazzo Table 80633
Black terrazzo
H: 130 Dia: 100mm
E27
7. Saroma Table 98496
Matt terracotta paint
H: 410 Dia: 180mm E14

4. Olivia Table 94506
Thyme glaze & satin nickel plate
H: 115 Dia: 80mm
E27
8. Wriggle Table 100958
Matt black & natural raffia
H: 457 Dia: 180mm E14



1. Waldorf Table 61198
Chrome glass & ivory fabric
H: 470 Dia: 320mm E27
2. Waldorf Table 61149
Copper glass & black fabric
H: 470 Dia: 320mm E27
3. Simeto Table EH-SIMETO-TL
Polished nickel & grey fabric
H: 580 Oval: 280-400mm E27
4. Syon Table USB 72175
Bright nickel & mink fabric
H: 515 Dia: 250mm E14
5. Epalle Table 96930-TLCH
Chrome plate & white fabric
H: 585 Rect: 160-360mm E14
6. Tramini Table TRAMINI
Silver plate & taupe silk
H: 445 Rect: 210-460mm E27
7. Raskin Task Table EH-RASKIN-TL
Polished nickel plate
H: 330-695 W: 455 D: 140mm E14
8. Carlo Task Table 95460
Brushed chrome plate & grey marble
H: 605 W: 350 D: 170mm E27
9. Balin Task Table 95459
Brushed chrome plate
H: 490-580 W: 150 D: 315mm E27

















1. Leaf Table Base LEAF-TL-S
Polished nickel plate
H: 475 Dia: 125mm E27
5. Leaf & Freya Fir Shade 91223
Polished nickel plate & fir silk
H: 675 Dia: 355mm E27
9. Leaf & Freya Oyster Shade 91228
Polished nickel plate & oyster silk
H: 645 Dia: 305mm E27

2. Leaf & Freya Charcoal Shade 91219
Polished nickel plate & charcoal grey silk
H: 675 Dia: 355mm E27
6. Leaf & Freya Charcoal Shade 91225
Polished nickel plate & charcoal grey silk H: 645 Dia: 305mm E27
10. Leaf & Freya Fir Shade 91229
Polished nickel plate & fir silk H: 645 Dia: 305mm E27



3. Leaf & Freya Dusky Pink Shade 91221
Polished nickel plate & dusky pink silk H: 675 Dia: 355mm E27
7. Leaf & Freya Silver Shade 91226
Polished nickel plate & silver silk H: 645 Dia: 305mm E27

4. Leaf & Freya Oyster Shade 91222
Polished nickel plate & oyster silk
H: 675 Dia: 355mm E27
8. Leaf & Freya Dusky Pink Shade 91227
Polished nickel plate & dusky pink silk
H: 645 Dia: 305mm E27


1. Leaf Tall Table Base EH-LEAF-TL-L
Polished nickel plate
H: 785 Dia: 145mm E27
2. Leaf Tall & Freya Charcoal Shade 91157
Polished nickel plate & charcoal grey silk
H: 985 Dia: 355mm E27
3. Leaf Tall & Freya Dusky Pink Shade 91159
Polished nickel plate & dusky pink silk
H: 985 Dia: 355mm E27
4. Leaf Tall & Freya Oyster Shade 91160
Polished nickel plate & oyster silk
H: 985 Dia: 355mm E27
5. Leaf Tall & Freya Fir Shade 91161
Polished nickel plate & fir silk
H: 985 Dia: 355mm E27
6. Leaf Tall & Evie Navy Shade 91167
Polished nickel plate & navy cotton
H: 985 Dia: 355mm E27
7. Leaf Tall & Evie Yellow Shade 91168
Polished nickel plate & yellow cotton
H: 985 Dia: 355mm E27
8. Leaf Tall & Mia Vintage White Shade 91169
Polished nickel plate & vintage white linen
H: 1010 Dia: 350mm E27
9. Leaf Tall & Mia Natural Shade 91171
Polished nickel plate & natural linen
H: 1010 Dia: 350mm E27














































Distinctive domed shade and smart curved arm, perfect for modern settings.



in AUTUMN / WINTER 23







The task table features a USB port perfect for charging smart devices.










Matt black & matt opal glass H: 437 Dia: 130mm G9
E27








1. Fraser Table 95467
Satin brass plate & natural linen mix fabric
H: 600 Sh H: 350 Dia: 200mm E27
5. Abia Table 95455
Oak effect resin & natural linen
H: 680 Dia: 330mm E27
2. Fraser Floor 95466
Satin brass plate & natural linen mix fabric
H: 1650 Sh H: 600 Dia: 324mm E27
6. Abia Floor 95454
Oak effect resin & natural linen
H: 1585 Dia: 420mm E27




3. Josephine Table 72389
Bright nickel plate & vintage white fabric
H: 450 W: 200 D: 250mm E14
7. Andromeda Table 71621
Satin chrome plate & vintage white fabric
H: 600 Dia: 315mm E27 & 2.87W Int. LED 100 lumens warm white


4. Josephine Floor 72388
Bright nickel plate & vintage white fabric
H: 1520 W: 450 D: 665mm E27
8. Andromeda Floor 71620
Satin chrome plate & vintage white fabric
H: 1555 Dia: 400mm E27 & 2.87W Int. LED 100 lumens warm white




A sophisticated and stylish collection of tripod table and floor lamps, each with matching fabric shades for a relaxed, clean-line interior aesthetic.














Stylish task and floor lamps featuring an easy accessible on / off switch with knurled detailing.
1.
3. Mayfield Task Table 95470 Brushed silver plate & matt black H: 585 W: 160 D: 265mm E27
5.













1. Marshall Task Floor 90592
Slate grey H: 1700 W: 380 D: 900-1500mm E27
5. Hackney Touch Task Floor
656-FL-AN
Antique brass plate
H: 1120-1590 W: 250 D: 500mm G9
Slate grey H: 720 W: 200 D: 300-500mm E27
6. Hackney Touch Task Table
656-TL-AN
Antique brass plate
H: 355-570 W: 170 D: 370mm G9
7. Hackney Touch Task Table
656-TL-SC
Satin chrome plate
H: 355-570 W: 170 D: 370mm G9






6.











1. Oslo Floor Base OSLO-FL-AN
Antique brass plate
H: 1350 Dia: 255mm E27
5. Oslo & Freya Silver Shade 91152
Antique brass plate & silver silk
H: 480 Dia: 305mm E27
9. Oslo & Freya Charcoal Shade 91085
Antique brass plate & charcoal grey silk
H: 525 Dia: 305mm E27
13. Oslo & Freya Fir Shade 91089
Antique brass plate & fir silk
H: 525 Dia: 305mm E27
2. Oslo 310mm Table Base OSLO-S-AN
Antique brass plate
H: 310 Dia: 110mm E27
6. Oslo & Freya Dusky Pink Shade 91153
Antique brass plate & dusky pink silk
H: 480 Dia: 305mm E27
10. Oslo & Freya Silver Shade 91086
Antique brass plate & silver silk
H: 525 Dia: 305mm E27
14. Oslo & Evie Navy Shade 91095
Antique brass plate & navy cotton H: 555 Dia: 355mm E27
3. Oslo 355mm Table Base OSLO-M-AN
Antique brass plate H: 355 Dia: 155mm E27
7. Oslo & Freya Oyster Shade 91154
Antique brass plate & oyster silk
H: 480 Dia: 305mm E27
11. Oslo & Freya Dusky Pink Shade 91087 Antique brass
15.
























































1. Suki Floor Base 98256 Antique brass plate
H: 1310 Dia: 230mm E27
5. Altesse 2lt Floor ALTESSE-FLNI Natural wood & oatmeal fabric H: 1710 Oval: 330-500mm
2 x E27
9. Nautical Floor EH-NAUTICAL-FL Polished nickel plate & black paint
H: 1170-1720 Dia: 770mm E27


2. Suki Floor Base 98263 Bright nickel plate H: 1310 Dia: 230mm E27
6. Rion Floor Base 93131 Polished aluminium H: 1310 Dia: 235mm E27
10. Tripod Floor Base 95153 Matt black finish H: 1290 Dia: 650mm E27




3. Suki Floor & Chatsworth Shade 100370 Antique brass plate & ivory silk H: 1535 Dia: 405mm E27
7. Tripod Floor Base EH-TRIPOD-FLDW Light mango wood & brass plate H: 690-1440 Dia: 780mm E27
11. Tripod Floor & Cylinder Shade 103798 Matt black & black fabric H: 1480 W: 500mm E27



4. Suki Floor & Chatsworth Shade 100375
Bright nickel plate & ivory silk H: 1535 Dia: 405mm E27
8. Tripod Floor Base EH-TRIPOD-FLBL Dark mango wood & bright nickel plate H: 690-1440 Dia: 780mm E27
12. Tripod Floor & Cylinder Shade 100365
Matt black & vintage white fabric H: 1480mm Dia: 500mm E27










1. Alassio Mother & Child Task Floor
73081
Satin chrome plate & frosted plastic
H: 1800 Dia: 300mm
18W & 6W Int. LED 1480 & 555 lumens
warm white
3. Monaco Mother & Child Task Floor
MONACO-SC
Satin chrome plate & frosted glass
H: 1820 Dia: 325mm
R7s & G9
5. Rome Mother & Child Task Floor
ROME-CH
Chrome plate & opal glass
H: 1800 Dia: 505mm
R7s & G9
7. Rome Mother & Child Task Floor
ROME-SB
Satin brass plate & opal glass
H: 1800 Dia: 505mm R7s & G9
9. Rome Mother & Child Task Floor
ROME-BC
Black chrome plate & opal glass
H: 1800 Dia: 505mm
R7s & G9
2. Alassio Mother & Child Task Floor
73080
Antique brass plate & frosted plastic
H: 1800 Dia: 300mm
18W & 6W Int. LED 1480 & 555 lumens
warm white
4. Monaco Mother & Child Task Floor
MONACO-AN
Antique brass plate & frosted glass
H: 1820 Dia: 325mm
R7s & G9
6. Rome Mother & Child Task Floor
ROME-SC
Satin chrome plate & opal glass
H: 1800 Dia: 505mm
R7s & G9
8. Rome Mother & Child Task Floor
ROME-AN
Antique brass plate & opal glass
H: 1800 Dia: 505mm
R7s & G9












































Cylinder 20”
1. Black fabric 101181
2. Vintage white fabric 77515 H: 240 Dia: 500mm
Rectangle 10.5” Shade
5. Grey fabric 77476
H: 170 D: 120 W: 270mm
E27/B22 with fixed gimble


16” Shade
H: 250 W: 410 D: 225mm
6. Medium 74417 H: 205 W: 420 D: 180mm
74418 H: 230 W: 460 D:
















Cici
1. 8” 66204 H: 135 Dia: 205mm
2. 10” CICI-10GRY H: 170 Dia: 260mm
3. 12” CICI-12GRY H: 205 Dia: 310mm
4. 14” CICI-14GRY H: 220 Dia: 355mm
5. 16” CICI-16GRY H: 260 Dia: 405mm
6. 18” CICI-18GRY H: 285 Dia: 455mm Grey linen mix fabric
E27/B22 (8” E14) with fixed gimble

Cici
7. 8” 66205 H: 135 Dia: 205mm
8. 10” CICI-10IV H: 170 Dia: 260mm
9. 12” CICI-12IV H: 205 Dia: 310mm
10. 14” CICI-14IV H: 220 Dia: 355mm
11. 16” CICI-16IV H: 260 Dia: 405mm
12. 18” CICI-18IV H: 285 Dia: 455mm Ivory linen mix fabric E27/B22 (8” E14) with fixed gimble












Freya 12” Shade
1. Charcoal grey silk 79626
2. Silver silk 79629
3. Dusky pink silk 79632
4. Oyster silk 81388
5. Fir silk 81390
H: 190 Dia: 305mm
E27/B22 with reversible gimble
Wentworth 8” Shade
10. Midnight blue silk 94387
H: 140 Dia: 205mm
E27/B22 with reversible gimble


6. Charcoal grey silk 79628
7. Dusky pink silk 79633
8. Oyster silk 81389
9. Fir silk 81391
H: 220 Dia: 355mm
E27/B22 with reversible gimble
Wentworth 12” Shade
11. Midnight blue silk 94384
H: 210 Dia: 305mm
E27/B22 with fixed gimble









Chatsworth 8” Shade
1. Ivory silk 94362
H: 140 Dia: 200mm
E14/B22
Chatsworth 10” Double Pinch Shade
2. Ivory silk 94355
H: 165 Dia: 255mm E27/B22
Chatsworth 12” Shade
3. Ivory silk 94352
H: 195 Dia: 305mm E27/B22
Chatsworth 14” Shade
4. Ivory silk 94353
H: 213 Dia: 355mm
E27/B22




Chatsworth 16” Shade
5. Ivory silk 94354
H: 260 Dia: 405mm
E27/B22
Carla 6” Shade
6. 6” CARLA-6 H: 120 Dia: 150mm
Cream fabric
E14/B22 with candle clip
Carla
7. 10” CARLA-10 H: 190 Dia: 260mm
8. 12” CARLA-12 H: 205 Dia: 310mm
9. 14” CARLA-14 H: 230 Dia: 360mm
10. 16” CARLA-16 H: 245 Dia: 410mm
11. 18” CARLA-18 H: 270 Dia: 460mm
12. 22” CARLA-22 H: 305 Dia: 560mm E27/B22 with fixed gimble




















Celia
1. 12” CELIA-12 H: 220 Oval: 230-310mm
2. 14” CELIA-14 H: 245 Oval: 280-365mm
3. 16” CELIA-16 H: 280 Oval: 315-415mm
4. 20” CELIA-20 H: 355 Oval: 395-515mm
Cream fabric
E27/B22 with fixed gimble
16” requires 7” carrier. 20” requires 9” carrier.
Carrie
5. 12” CARRIE-12 H: 245 Dia: 310mm
6. 14” CARRIE-14 H: 265 Dia: 360mm
7. 16” CARRIE-16 H: 285 Dia: 410mm
8. 18” CARRIE-18 H: 310 Dia: 460mm
9. 22” CARRIE-22 H: 370 Dia: 560mm Cream fabric
E27/B22 with fixed gimble
16” & 18” requires 7” carrier. 22” requires 9” carrier.




3.
4.
E27/B22 with reversible gimble















































Fully rotating and adjustable heads feature on these spotlight ranges, with a style to suit every interior.






1. Wyatt 3lt Bar 96801
Antique brass plate
Proj: 170-260 W: 800 D: 150-340mm
3 x E14
3. Rez 3lt Plate 98456
Matt black
Proj: 116-170 L: 700 D: 60-150mm
3 x GU10
2. Wyatt 3lt Round 96802
Antique brass plate
Proj: 180-260 Dia: 360-560mm 3 x E14
4. Rez 5lt Bar 98458
Matt black
Proj: 413-465 L: 1105 D: 60-150mm 5 x GU10







1. Gull Single Plate 59931
Matt white & brushed brass plate
Proj: 140 Dia: 80mm GU10
2. Gull 3lt Round 59932
Matt white & brushed brass plate
Proj: 155 Dia: 220mm 3 x GU10
3. Gull 4lt Bar 59933
Matt white & brushed brass plate
Proj: 180 L: 660 W: 80mm 4 x GU10
4. Westbury Single Plate 76277
Antique brass plate
Proj: 165 H: 125 W: 92mm GU10
5. Westbury 3lt Round 76279
Antique brass plate
Proj: 155 Dia: 280mm 3 x GU10
6. Westbury 4lt Plate 76280
Antique brass plate
Proj: 155 L: 650 W: 80mm 4 x GU10















































1. Talo 4lt Semi Flush 96160
Satin brass plate & clear ribbed glass
Proj: 108 Dia: 350mm
4 x G9
IP44
2. Talo Wall 96163
Satin brass plate & clear ribbed glass
Proj: 128 H: 295 W: 110mm
G9

IP44





1. Cheswick Flush 96138
Chrome plate & clear glass
Proj: 245 Dia: 200mm E27
IP44
2.
Chrome plate & clear glass
Proj: 195 H: 298 W: 150mm E14 IP44



Captivating collection with hoops, adding a contemporary edge to any bathroom.








Crystal and decorative glass details all with IP44 rating.










1. Alisona Flush 95987
Chrome plate & clear crystal glass
Proj: 400 Dia: 350mm
5. Elston Flush 95994
Chrome plate & clear dimpled glass
Proj: 300 Dia: 240mm
9. Chryla 3lt Flush 60103
Chrome plate & clear crystal
Proj: 135 Dia: 305mm 3 x G9
2. Alisona 4lt Flush 95989
Chrome plate & clear crystal glass
Proj: 400 Dia: 490mm
6. Milston Flush 96488
Chrome plate & clear spiral glass
Proj: 300 Dia: 240mm
10. Belfont 3lt Flush 61252
Clear crystal, frosted glass & chrome plate
Proj: 120 Dia: 300mm
3. Iona Flush 96005
Chrome plate & clear crystal glass
Proj: 285 Dia: 285mm
7. Cheston Flush 96489
Chrome plate & clear ribbed glass
Proj: 300 Dia: 240mm
4. Kristen 3lt Flush 61233
Clear crystal & chrome plate
Proj: 275 Dia: 290mm
x G9
8. Hamilton 3lt Semi Flush 96022
Chrome plate & clear crystal glass
Proj: 340 Dia: 355mm
x G9


Clear crystal & chrome plate
H: 830-1300 Dia: 600mm
8 x G9 IP44

Clear crystal & chrome plate
H: 710-1100 Dia: 490mm 5 x G9 IP44



Clear crystal & chrome plate
Proj: 545 Dia: 460mm 3 x G9

Clear crystal & chrome plate
Proj: 180 H: 295 W: 295mm 2 x G9
Add sumptuous elegance to your bathroom with this waterfall-style crystal chandelier range.






Proj: 160 Dia: 450mm







1.
IP44
3.
IP44
5.
Available in chrome, satin brass & matt black; ideal for co-ordinating with your bathroom fixtures.



Combining matt black steel with matt white glass to create modern silhouettes with an ambient glow.


















1. Hampton Wall 76304
Clear glass & chrome plate
Proj: 200 H: 280 W: 140mm E14 IP44
5. Conway Wall 93851
Chrome plate & ivory fabric
Proj: 240 H: 250 W: 150mm G9 IP44
9. Newham 2lt Wall 96137
Chrome plate & frosted glass
Proj: 75 H: 315 W: 75mm 2 x G9 IP44
2. Ashbury Wall 77088
Clear glass & chrome plate
Proj: 215 H: 270 W: 150mm E14 IP44
6. Conway Wall 93852
Satin brass plate & ivory fabric
Proj: 240 H: 250 W: 150mm G9 IP44
10. Newham Wall 96219
Chrome plate & frosted glass
Proj: 75 H: 215 W: 75mm G9 IP44
3. Faraday Wall 93854
Satin brass plate & clear glass
Proj: 150-350 H: 150-330 W: 150mm G9 IP44
7. Shore 2lt Wall 447
Chrome plate & clear/frosted glass
Proj: 200 H: 160 W: 225mm 2 x G9 IP44
11. Newham 2lt Wall 96220
Chrome plate & clear ribbed glass
Proj: 75 H: 315 W: 75mm 2 x G9
4. Faraday Wall 93853
Chrome plate & clear glass
Proj: 150-350 H: 150-330 W: 150mm G9 IP44
8. Britton Wall 51885
Chrome plate with clear and frosted glass
Proj: 130 H: 155 W: 85mm G9 IP44
12. Newham Wall 96221
Chrome plate & clear ribbed glass
Proj: 75 H: 215 W: 75mm G9 IP44








Can be mounted vertical or horizontal

1. Essence 5lt Flush 70330
Chrome plate & clear bubble acrylic
Proj: 170 Dia: 370mm
17.3W Int. LED 1243 lumens warm white LED IP44
2. Essence 3lt Flush 70254
Chrome plate & clear bubble acrylic
Proj: 165 Dia: 320mm 10.3W Int. LED 750 lumens warm white LED IP44 3. Essence 2lt Wall 72612
Chrome plate & clear bubble acrylic
Proj: 85 H: 260 W: 65mm 6.9W Int. LED 473 lumens warm white

4. Essence Wall 72046
Chrome plate & clear bubble acrylic
Proj: 80 H: 140 W: 80mm 4.1W Int. LED 220 lumens warm white LED IP44


Add some interest and modern styling with unique clear bubble inserts.



1. Versa 5lt Flush 76365
Chrome plate & clear bubble acrylic
Proj: 130 Dia: 280mm
18W Int. LED 905 lumens warm white
IP44
3. Imperial 5lt Flush 61358
Chrome plate & clear bubble glass
Proj: 110 Dia: 300mm
20W Int. LED 1150 lumens warm white
IP44
Chrome plate & clear bubble acrylic
Proj: 130 Dia: 220mm
12W Int. LED 488 lumens warm white







1. Onan Shaver 68930
Opal pc & chrome acrylic
Proj: 70 H: 80 W: 520mm 12W Int. LED 600 lumens cool white
3. Moda Wall 76657
Chrome effect & frosted plastic
Proj: 132 H: 42 L: 400mm 8W Int. LED 640 lumens daylight white
5. Moda Wall 76656
White ribbed & chrome effect plastic
Proj: 70 H: 52 W: 598mm 15W Int. LED 1200 lumens daylight white
2. Onan Shaver 70443
Opal pc & white acrylic
Proj: 70 H: 80 W: 520mm 12W Int. LED 600 lumens cool white
4. Axis Wall 76658
Chrome effect & frosted plastic
Proj: 120 H: 42 W: 400mm 8W Int. LED 640 lumens daylight white
6. Nero Shaver IR Mirror 91833
Mirrored glass & silver paint H: 700 W: 500 Proj: 50mm 9.8W Int. LED 290 lumens cool white















































79792
Textured matt black & clear glass
Proj: 160 H: 300 W: 100mm
96917
3.
Textured black & clear glass
Proj: 195 H: 350 W: 130mm
5. Herbert Wall 91993
Textured black
Proj: 140 H: 270 W: 110mm
E27


2. North Wall 71184
Brushed stainless steel & clear glass
Proj: 160 H: 300 W: 100mm
4. Braden Wall 96916
Textured black & white pc
Proj: 200 H: 270 W: 160mm






1. Oxford PIR Wall 94995
Matt black & clear glass
Proj: 127 H: 238 W: 120mm
5. Canon Wall EL-40094
Polished stainless steel & clear glass
Proj: 110 H: 115 W: 60mm
9. Helm Wall 96904
Textured black & clear glass
Proj: 88 H: 157 W: 125mm
2. Oxford Wall 80600
Matt black & clear glass
Proj: 110 H: 235 W: 115mm
6. Canon 2lt Wall EL-40095
Polished stainless steel & clear glass
Proj: 110 H: 165 W: 60mm
10. Helm 2lt Wall 96905
Textured black & clear glass
Proj: 88 H: 157 W: 125mm
3. Oxford Wall 53803
Brushed stainless steel & clear glass
Proj: 110 H: 235 W: 115mm
7. Canon PIR Wall EL-40063
Polished stainless steel & clear glass
Proj: 110 H: 150 W: 70mm
11. Milton Wall 96910
Textured black & clear glass
Proj: 115 H: 132 W: 80mm








4. Oxford PIR Wall 96088
Brushed stainless steel & clear glass
127 H: 238 W: 120mm
8. Canon PIR 2lt Wall EL-40062
Polished stainless steel & clear glass Proj: 105 H: 210 W: 70mm
x GU10
12. Milton 2lt Wall 96911
Textured black & clear glass
Proj: 115 H: 184 W: 80mm







1. Dexter Wall PIR 74702
Polished stainless steel & clear glass
Proj: 255 H: 325 W: 220mm
3. Seraph Wall 70695
Textured grey paint & clear pc
Proj: 295 H: 325 W: 230mm


2. Grant 2lt Wall YG-7501
Polished stainless steel & clear crystal
Proj: 110 H: 230 W: 60mm
1.6W Int. LED 110 lumens daylight white
4. Bayswater Wall EL-40045
Black polypropylene & clear glass
Proj: 212 H: 355 W: 170mm


















Make a smart and stylish statement with this collection of fisherman and farmhouse inspired outdoor wall lights.





EASY INSTALLATION
No wiring and no installation costs
SAVE MONEY & THE ENVIRONMENT
Solar energy powered by sunlight
DESIGN & QUALITY
Stylish solar designs to illuminate outside spaces
Three intelligent modes to choose from...
MODE ONE (CONSTANT)
Automatically illuminates at dusk with low light
MODE TWO (BOOST)
Automatically illuminates at dusk with low light and gets brighter when motion is detected
MODE THREE (SECURITY)
Only illuminates when motion is detected with bright light for 25 seconds








1.
5.88W
3. Halton Post Photocell & PIR 96926
Brushed
4. Halton Bollard Photocell & PIR 96927









1. Ebro Wall Photocell & PIR 96933
Textured black & white pc
Proj: 187 H: 90 W: 160mm
5.88W Int. LED 290 lumens warm white LED IP44 inc
5. Hallam Bollard Photocell & PIR 96930
Textured black & white pc
H: 600 Sq: 100mm
2.7W Int. LED 180 lumens warm white LED IP44 inc
2. Ebro Post Photocell & PIR 96934
Textured black & white pc
H: 500 W: 160 D: 202mm
5.88W Int. LED 290 lumens warm white LED IP44 inc
6. Hallam Post Photocell & PIR 96929
Textured black & white pc
H: 400 Sq: 100mm
2.7W Int. LED 180 lumens warm white
IP44 inc





3. Dannah Bollard Photocell & PIR 96936
Textured black & white pc
H: 800 W: 200 D: 60mm
5.88W Int. LED 320 lumens warm white LED IP44 inc
7. Hallam Wall Photocell & PIR 96928
Textured black & white pc
Proj: 126 H: 170 W: 100mm
2.7W Int. LED 180 lumens warm white
4. Dannah Post Photocell & PIR 96935
Textured black & white pc
H: 500 W: 200 D: 60mm
5.88W Int. LED 320 lumens warm white
IP44 inc
8 Tarrow Wall Photocell & PIR 106467
Matt black & white pc
Proj: 208 H: 312 W: 160mm
1.7W Int. LED 85 lumens warm white LED IP44 inc




Spike 5. Hoot Medium Rechargeable Table






3. Tallow Rechargeable Table 4. Voyage Rechargeable Table 2. Tropic Solar Table

Hoot Large Rechargeable Table
1. Dusk Solar Floor Spike 106476
2. Tropic Solar Table 106477


8.
Solar / Rechargeable Table 7. Linterna Solar / Rechargeable Table
Tallow Table 106800
4. Voyage Table 106801
5. Hoot Medium Table 106789
6. Hoot Large Table 106790
7. Linterna Table 96931
8. Linterna Table 96932




1. Quinn Wall 96922 Textured
3. Equinox
From portable table lights to PIR sensors; transform your outdoor space into a stunning oasis with practical and stylish garden lighting.



Fitted with vandal resistant diffusers making it suitable for front gardens and commercial properties.








Polished stainless steel & clear pc
H: 425-880 Dia: 165mm



Polished stainless steel & clear pc
Proj: 215 H: 315 W: 165mm
Polished stainless steel & clear pc
Proj: 215 H: 315 W: 165mm


















Textured black & clear glass H: 470 Dia: 200mm

Textured black & clear
4. Drayton
Textured black & clear glass
H: 590-980 Dia: 200mm



















































1. Opaline E27 Filament 102615
Opal glass
H: 140 Dia: 95mm 12W LED E27 1400 lumens warm
2. Opaline E27 Filament 102614
Opal glass
170 Dia: 125mm
3. Twist E27 Filament 98144
Amber glass
142 Dia:
4. Spiral E27 Filament 102620
Amber glass H: 241 Dia: 200mm 4W LED E27 320 lumens
5. Swirl E27 Filament 102622
Amber glass H: 242 Dia: 190mm
6. Helix E27 Filament 98083
Smoked glass
H: 242 Dia: 190mm 4W E27 50 lumens
7. Spiral E27 Filament 102617
Smoked glass
140 Dia:
8. Spiral E27 Filament 102616
Smoked glass
H: 170 Dia: 125mm 4W LED E27 80 lumens warm white
9. Wisp E27 Filament 98082
Smoked glass
H: 308 Dia: 173mm 4W E27 50 lumens warm white




1. Aylo Grey E27 LED 98081
Clear & grey textured glass
H: 164 Dia: 125mm
3W E27 155 lumens warm white
5. Beehive E27 LED 97178
Amber glass
H: 178 Dia: 130mm
2.5W E27 120 lumens warm white

2. Firefly E27 LED 97223
Frosted textured glass
H: 165 Dia: 125mm 1W E27 50 lumens warm white
6. Dimple E27 LED 97175
Amber glass H: 164 Dia: 125mm
2.5W E27 120 lumens warm white



3. Firefly E27 LED 97224
Clear glass H: 165 Dia: 125mm 1W E27 50 lumens warm white
7. Lines E27 LED 97177
Amber glass H: 174 Dia: 130mm 2.5W E27 120 lumens warm white


4. Facett E27 LED 97176
Amber glass
H: 174 Dia: 125mm
2.5W E27 120 lumens warm white
8. Scandi E27 LED 97179
Amber glass H: 163 Dia: 123mm
2.5W E27 120 lumens warm white





















1. XL E27 LED Dimple Globe 148mm dia 77085
Amber glass
H: 243 Dia: 148mm
2.5W E27 140 lumens warm white
5. E27 LED Globe 200mm dia 80169
Amber glass
H: 241 Dia: 200mm
2.8W LED E27 120 lumens warm white
9. E27 LED Ribb Globe 125mm dia 80179
Amber glass
H: 175 Dia: 125mm
4W LED E27 400 lumens warm white
2. XL E27 LED Globe 148mm dia 77084
Amber glass
H: 243 Dia: 148mm
2.5W E27 140 lumens warm white
6. E27 LED Globe 200mm dia 80170
Smoked glass
H: 241 Dia: 200mm
2.8W LED E27 55 lumens warm white
10. E27 LED Ribb Globe 125mm dia 80632
Clear glass
H: 175 Dia: 125mm
4W LED E27 480 lumens warm white
3. XL E27 LED Dimple Globe 148mm dia 77113
Clear glass
H: 243 Dia: 148mm
2.5W E27 140 lumens warm white
7. E27 LED Globe 200mm dia 80168
Clear glass
H: 241 Dia: 200mm
2.8W LED E27 120 lumens warm white
11. E27 LED Facet Globe 125mm dia 80182
Clear glass
H: 175 Dia: 125mm 4W LED E27 480 lumens warm white


4. XL E27 LED Globe 148mm dia 77112
Clear glass
H: 243 Dia: 148mm
2.5W E27 140 lumens warm white
8. E27 LED Ribb Pear 80180
Clear glass
H: 160 Dia: 60mm 4W LED E27 470 lumens warm white
12. Groove E27 LED Filament 125mm dia 80184
Clear glass
H: 175 Dia: 125mm 4W E27 480 lumens warm white














1. E27 LED Filament Globe 125mm dia 77110
Clear glass H: 170 Dia: 125mm 2W E27 230 lumens warm white
2. E27 LED Filament Globe 95mm dia 77108
Clear glass H: 135 Dia: 95mm 2W E27 230 lumens warm white
3. E27 LED Filament Pear 77106
Clear glass H: 140 Dia: 64mm
2W E27 230 lumens warm white
4. E27 LED Filament Globe 125mm dia 77111
Amber glass
H: 170 Dia: 125mm 2W E27 230 lumens warm white
5. E27 LED Filament Globe 95mm dia 77109
Amber glass H: 135 Dia: 95mm 2W E27 200 lumens warm white
6. E27 LED Filament Pear 77107
Amber glass H: 140 Dia: 64mm
2W E27 210 lumens warm white
7. E27 LED Filament Globe 125mm dia 93024






Clear glass H: 165 Dia: 125mm
6W E27 650 lumens warm white
8. E27 LED Filament Globe 95mm dia 93023
Clear glass H: 135 Dia: 95mm 6W E27 650 lumens warm white
9. E27 LED Filament Pear 93025
Clear glass H: 140 Dia: 64mm 6W E27 650 lumens warm white




10. E27 LED Filament Globe 125mm dia 93031
Amber glass H: 165 Dia: 125mm 6W E27 540 lumens warm white
11. E27 LED Filament Globe 95mm dia 93030
Amber glass H: 135 Dia: 95mm 6W E27 540 lumens warm white
12. E27 LED Filament Pear 93032
Amber glass H: 140 Dia: 64mm 6W E27 540 lumens warm white









1. E27 LED Filament GLS 93021
Clear glass
H: 105 Dia: 60mm
6W E27 650 lumens warm white
2. E14 LED Filament Candle 93020
Clear glass
H: 98 Dia: 35mm
4W E14 420 lumens warm white
3. E14 LED Filament Golf 93019
Clear glass
H: 80 Dia: 45mm
4W E14 420 lumens warm white
4. E27 LED Filament GLS 93028
Amber glass
H: 105 Dia: 60mm
6W E27 540 lumens warm white
5. B22 LED Filament GLS 93029
Amber glass
H: 102 Dia: 60mm
6W B22 540 lumens warm white
6. E14 LED Filament Candle 93027
Amber glass
H: 98 Dia: 35mm
4W E14 360 lumens warm white







G9 Halogen
1. GU10 LED SMD 60° 97114
Matt white plastic & clear prismatic
H: 54 Dia: 50mm
7W GU10 585 lumens cool white
5. G9 LED SMD 104037
Clear & white PC
H: 50 Dia: 16mm
3.5W G9 400 lumens warm white
9. G9 LED SMD Dimmable 108451
Clear & white PC
H: 49 Dia: 16mm
3.7W G9 470 lumens warm white
13. G9 Halogen Dimmable 107554
Clear glass
H: 42 Dia: 13mm
28W G9 370 lumens warm white

2. GU10 LED SMD 97118
Clear glass
H: 52 Dia: 50mm
6W GU10 470 lumens cool white
6. G9 LED SMD 104038
Clear & white PC
H: 50 Dia: 16mm
3.5W G9 400 lumens cool white
10. G9 LED SMD Dimmable 108452
Clear & white PC
H: 49 Dia: 16mm
3.7W G9 470 lumens cool white
14. R7s Halogen Dimmable 107525
Clear glass & unglazed ceramic
L: 118 Dia: 9mm
120W R7s 2250 lumens warm white

GU10 LED SMD 60º






3. GU10 LED SMD 60° 104033 White & clear prismatic PC
H: 54 Dia: 50mm
7W GU10 680 lumens warm white
7. G9 LED SMD 104039
Clear & white PC
H: 50 Dia: 16mm
4.8W G9 470 lumens warm white
11. G9 LED Frosted SMD 104035 Frosted PC
H: 48 Dia: 16mm
2W G9 200 lumens warm white
15. Harper T5 LED Tube Small S-104001
Opal glass & gloss white plastic
L: 560 Dia: 18mm 8W T5 1050 lumens daylight white

4. GU10 LED SMD 60° 104034
White & clear prismatic PC
H: 54 Dia: 50mm
7W GU10 680 lumens cool white
8. G9 LED SMD 104040
Clear & white PC
H: 50 Dia: 16mm
4.8W G9 470 lumens cool white
12. G9 LED Frosted SMD 104036
Frosted PC
H: 48 Dia: 16mm
2W G9 200 lumens cool white
16. Harper T5 LED Tube Large S-104002
Opal glass & gloss white plastic
L: 1165 Dia: 18mm
16W T5 2400 lumens daylight white




































Camille 24lt CAMILLE-24CH Page 68

Neve 3lt 76484 Page 124

5lt 69390 Page 83

Whistle 6lt WHISTLE-6NI Page 130


6lt 81931 Page 51


6lt 76511 Page 127



4lt 81930 Page 51

15lt 72746 Page 124





12lt 81981 Page 69 Malmsbury 6lt 94396 Page 31 Valetta 6lt 76430 Page 124





12lt 72744 Page 125

6lt 76508 Page 50
Loire 7lt 76512 Page 127 Amadis 6lt 96826-CH Page 126 Adagio 9lt 96819-GO Page 126
4lt 76509 Page 50




8lt 61294 Page 132

12lt 308-8-4CL Page 126

4lt 61281 Page 132

8lt 308-8CL Page 126

8lt 69391 Page 83

8lt KORA-8CH Page 138


1lt 80123 Page 129

Marella 8lt 76507 Page 50

5lt KORA-5CH Page 139

8lt KORA-8AB Page 138
Fiennes 5lt FIENNES-5NI Page 100 Indara 5lt 71345 Page 96 Kora 5lt KORA-5AB Page 138
6lt 92217 Page 54

8lt 80124 Page 129

12lt 76436 Page 124

6lt 80199 Page 129

1lt 97214 Page 127
28lt 77587 Page 18

12lt 81609 Page 35

2lt 97219 Page 127

28lt 76499 Page 18

12lt 61026 Page 132

5lt 97624 Page 137

11lt 76500 Page 18

8lt ASTAIRE-8SN Page 138

11lt 101147 Page 18

8lt 81979 Page 69

4lt 97628 Page 70

Zander 6lt 82016 Page 116
5lt ASTAIRE-5SN Page 138
4lt 95853 Page 116 Finsbury 5lt 73598 Page 107

6lt 76450 Page 129

5lt 76514 Page 85

1lt 97629 Page 137


Page 155

Hurst 3lt 76227 Page 120


3lt 95836 Page 120






3lt 102929 Page 117



2lt 101692 Page 27
3lt 101681 Page 29 Mathias 3lt 101698 Page 24
3lt 101775 Page 24


5lt 76520 Page 85 Verina 12lt 76518 Page 85




3lt 97623 Page 137










5lt 81923 Page 48





3lt 101678 Page 26






6lt 98113 Page 122






































































Eclipse 5lt 78697 Page 77

Hayfield 3lt 95834 Page 46

Highclere 8lt 99152 Page 78

Highclere 3lt 94394 Page 78

Daley 5lt 60257 Page 90

Ortona 5lt 95826 Page 89

Berenice 5lt 104108 Page 13

Ridgeton 3lt 106282 Page 15

Hayfield 3lt 72635 Page 46

Highclere 6lt 94373 Page 78

Nixon 6lt 60179 Page 94

Daley 3lt 73016 Page 90

Ortona 3lt 95828 Page 89

Berenice 5lt 107802 Page 13

Eldora 5lt 90299 Page 62

Daley 3lt 60241 Page 90

Highclere 6lt 98933 Page 81

Nixon 3lt 60129 Page 94

Daley 3lt 60256 Page 90

Phantom 7lt PHANTOM-7CH Page 138

Allegra 8lt 103172 Page 14

Eldora 5lt 81965 Page 62

Daley 3lt 73015 Page 90

Highclere 6lt 94357 Page 78

Nixon 6lt 70561 Page 94

Highclere 6lt 94381 Page 78

Alton 5lt 1805-5SC Page 102

Allegra 8lt 104051 Page 14


Cordero 3lt 101569 Page 30 MULTI ARM PENDANT
Cordero 3lt 81969 Page 30

Harvey 3lt 67667 Page 32

Highclere 6lt 94397 Page 78

Nixon 3lt 70560 Page 94

Highclere 6lt 98936 Page 81

Harvey 3lt 73021 Page 32

Highclere 3lt 94377 Page 78

Harvey 5lt 67734 Page 32

Highclere 6lt 99151 Page 78

Alton 5lt 1805-5AN Page 102

Highclere 8lt 94415 Page 78

Highclere 3lt 98934 Page 81

Harvey 5lt 73022 Page 32

Ortona 5lt 70245 Page 89

Alton 3lt 1805-3SC Page 102

Dimple 5lt 91969 Page 43

Hayfield 3lt 95839 Page 46

Highclere 8lt 98938 Page 81

Highclere 3lt 94361 Page 78

Daley 5lt 73017 Page 90

Ortona 3lt 73411 Page 89


Alton 3lt 1805-3AN Page 102

Dimple 5lt 97972 Page 43

Lullaby 5lt LULLABY-5CR Page 138
Easton 6lt 74128 Page 100

Lullaby 3lt LULLABY-3CR Page 138

Parkstone 8lt 2013-8CH Page 138

Parkstone 5lt 2013-5CH Page 138


Bernice 5lt 2030-5AS Page 103

Zaire 1lt 101688 Page 28 Zaire 1lt 101689 Page 28


Minato 1lt 101675 Page 128 Minato 1lt 101676 Page 128



Storni 1lt EH-STORNI-L Page 120


Esme 3lt 98152 Page 122




Bernice 5lt 2030-5AN Page 103


Bernice 3lt 2030-3AS Page 103

1lt 101777 Page 24



Bernice 3lt 2030-3AN Page 103



5lt 180-5AN Page 108 Trafford 5lt 180-5AS Page 108


1lt 101700 Page 24 Paloma 1lt 68956 Page 122 Paloma 1lt 68958 Page 122
1lt 101691 Page 27

1lt 68959 Page 122



1lt 101572 Page 128

1lt EH-TANARO-AB Page 126



Hurst 1lt 95835 Page 120


Grand 1lt 106896 Page 21

1lt 71123 Page 133 Storni 1lt EH-STORNI-S Page 120

1lt 71124 Page 132


Ribbed 4lt 106711 Page 119

1lt 101541 Page 120
Ribbed 1lt 106710 Page 119


1lt 94521 Page 129

4lt 70324 Page 119

Grand 1lt 106895 Page 21 Caspa 1lt 100046 Page 40
1lt 77272 Page 22

1lt 75664 Page 129


1lt 91738 Page 21

1lt 90563 Page 75

1lt 76332 Page 21
1lt 101574 Page 128 Lyra 1lt 106923 Page 17 Hansen Grand 1lt 102926 Page 22

1lt 95472 Page 75 Ebbe 1lt 95462 Page 132
4lt 69455 Page 119

1lt 70323 Page 119


1lt 69454 Page 119


1lt 73117 Page 132
1lt 69784 Page 132
3lt 73560 Page 132
1lt 73108 Page 126
1lt 73109 Page 126
1lt 76225 Page 120 Hadden 1lt 76228 Page 120














































































































Otto 5lt 75939 Page 72


4lt 75959 Page 72

5lt 95291 Page 151

Maye 6lt 97232 Page 150 Maye 6lt 97233 Page 150

Aerith 6lt 73582 Page 45

Aherne 3lt 73758 Page 152


3lt 73642 Page 45


6lt 76501 Page 18

6lt 76349 Page 152




3lt 97234 Page 151

6lt 101148 Page 18


3lt 96641 Page 150

3lt 95289 Page 151


3lt 97647 Page 150

3lt 95290 Page 151


3lt 97230 Page 150

3lt 96833 Page 151


3lt 97231 Page 150

3lt 97228 Page 151

5lt 76595 Page 44

5lt BOYER-5CH Page 98


3lt
Page 98

6lt 146-6CH Page 105

3lt
Page 104

Heston 1lt 61497 Page 97

3lt 146-3CH Page 105

3lt 76880 Page 152 Aherne 5lt AHERNE-5CH Page 152 Aherne 5lt 73757 Page 152
3lt 76285 Page 44

5lt
Page 98


3lt
Page 98


3lt 99569 Page 41 Mesmer 5lt 99570 Page 41 Hansen 3lt 97247 Page 22 Hansen 5lt 97248 Page 22
6lt 146-6AB Page 105

3lt 146-3AB Page 105

5lt LANGELLA-5CH Page 99


3lt
3lt
Page 99
Page 104 Firenz 1lt 387-30SC Page 155
1lt 97684 Page 155

1lt 96169 Page 155

Delphine 3lt 95039 Page 53 Delphine 3lt 98048 Page 53
1lt 96181 Page 155

1lt 101699 Page 24

1lt 96182 Page 155
1lt 96183 Page 155

1lt 101776 Page 24


1lt 101695 Page 27

3lt 81964 Page 62 Cordero 3lt 81966 Page 30
























































Meadow 2lt
2007-2WBCH Page 158

Cagney 1lt
CAGNEY-1WBSC Page 109

Boyer 2lt
BOYER-2WBCH-L Page 98

Rennes & Cici 1lt 103355 Page 162

Rouen & Cici 1lt 103363 Page 162

Harvey 1lt 69083 Page 32

Delphine 1lt 98049 Page 53

Petal 1lt 124-1 Page 101

Cagney 1lt
CAGNEY-1WBAB Page 109

Boyer 2lt
BOYER-2WBAB-L Page 98

Rennes & Carla 1lt 103356 Page 162

Rouen & Carla 1lt 103364 Page 162

Harvey 2lt 69092 Page 32

Delphine 1lt 95040 Page 53

Easton 1lt 76259 Page 100

Alton 1lt 1805-1SC Page 102

Bernice 2lt 2030-2AN Page 103

Rennes & Chatsworth 1lt 103357 Page 162

Rouen & Chatsworth 1lt 103366 Page 162

Ortona 1lt 95827 Page 89

Moreto 1lt MORETO-1WBCH Page 110

Berenice 1lt 104109 Page 13


Berenice 1lt 107803 Page 13


Hopton 1lt 104193 Page 16


Hopton 1lt 106003 Page 16


Otto 1lt 75960 Page 72

Alton 2lt 1805-2SC Page 102

Trafford 2lt 180-2AN Page 108

Rennes & Cici 1lt 103358 Page 162

Rouen & Cici 1lt 103367 Page 162

Ortona 1lt 70246 Page 89

Corvina 1lt CORVINA-1WB Page 111

Trafford 1lt 180-1AN Page 108

Rennes & Cici 1lt 103359 Page 162

Daley 1lt 73018 Page 90

Brio 1lt BRIO-1WBCH Page 88

Piccolo 1lt 96751-CH Page 158
Alton 2lt 1805-2AN Page 102
Alton 1lt 1805-1AN Page 102 Aerith 2lt 73583 Page 45 Havana 2lt 146-2CH Page 105

Finsbury 2lt 73584 Page 107

Rouen & Carla 1lt 103360 Page 162

Daley 1lt 61608 Page 90

Brio 1lt BRIO-1WBAB Page 88

Piccolo 1lt 61604 Page 158

Rennes & Carla 1lt 103346 Page 162

Rouen & Chatsworth 1lt 103361 Page 162

Harvey 1lt 73026 Page 32

Fiennes 1lt FIENNES-1WBNI Page 100

Domina 2lt DOMINA-2WBNI Page 158

Rennes & Chatsworth 1lt 103354 Page 162

Rouen & Cici 1lt 103362 Page 162

Harvey 2lt 73027 Page 32

Domina 1lt DOMINA-1WBNI Page 158

Highclere 2lt 94403 Page 78

Highclere 2lt 94406 Page 78


2lt 60180 Page 94

1lt 97611 Page 65



2lt 70562 Page 94

Marella 2lt 76510 Page 50 Marietta 1lt 99168 Page 12

Heston 1lt 61499 Page 97 Fargo 2lt FARGO-WBCH Page 61
Highclere 2lt 98937 Page 81 Malmesbury 1lt 94372 Page 31

1lt 104114 Page 12

2lt FARGO-WBBP Page 61

Secret garden 1lt 61684 Page 86

2lt 70118 Page 159



garden 1lt 70105 Page 86 Marconi 2lt MARCONI-2WBCH Page 158

Gianna 1lt 76570 Page 159



1lt 81932 Page 51

1lt 78700 Page 51

1lt 70334 Page 158

2lt MARCONI-2WBLI Page 158

1lt
Page 159

1lt WELLES-1WBSC Page 104



1lt 81976 Page 59

2lt 81978 Page 69


2lt HUDSON-2WBCH Page 58 Hudson 2lt 70559 Page 58


1lt 69392 Page 83 Verina 1lt 76515 Page 85




Page 159

Page 161

Page 161



1lt WELLES-1WBAB Page 104
Longshore 1lt 101690 Page 27
1lt 70335 Page 158 Indara 1lt 71308 Page 96

1lt 143-WB Page 159

1lt 97877 Page 162 Rouen 1lt 97875 Page 162 Rouen 1lt 97880 Page 162
Page 161




1lt 61031 Page 159

1lt 97872 Page 162













































































































































































Adelie & Freya 1lt 100353 Page 182 Adelie & Freya 1lt 100354 Page 182


Wistow & Mia 1lt 91213 Page 172 Wistow & Mia 1lt 91215 Page 172

Jemma & Mia 1lt 92892 Page 180


& Evie 1lt 92897 Page 180






Adelie & Freya 1lt 100355 Page 182 Adelie & Freya 1lt 100356 Page 182 Adelie & Freya 1lt 100357 Page 182 Adelie & Cici 1lt 100359 Page 182 Adelie & Cici 1lt 100360 Page 182

& Cici 1lt 106274 Page 17

& Evie 1lt 92898 Page 180


& Cici 1lt 106275 Page 17

& Mia 1lt 92899 Page 180




Raffia 1lt 106277 Page 17

& Mia 1lt 92901 Page 180



Adelie & Wentworth 1lt 100363 Page 182

& Evie 1lt 92889 Page 180

& Evie 1lt 92907 Page 180



& Cici 1lt 98387 Page 179


1lt 103375 Page 178

& Carla 1lt 103380 Page 178
1lt 96105 Page 179
1lt 94367 Page 172

1lt 81909 Page 180

1lt 90566 Page 179

1lt 93003 Page 171

1lt
Page 187

1lt 93005 Page 183

1lt
Page 186

1lt 98067 Page 183

Med 1lt OSLO-M-AN Page 199

1lt 98106 Page 183

Sml 1lt OSLO-S-AN Page 199
& Cici 1lt 103376 Page 178

1lt 100910 Page 17 Jemma & Evie 1lt 92888 Page 180 Jemma & Evie 1lt 92906 Page 180


& Mia 1lt 92890 Page 180 Jemma & Mia 1lt 92908 Page 180 Jemma & Mia 1lt 92910 Page 180
& Cici 1lt 103377 Page 178 Provence & Carla 1lt 103379 Page 178

1lt 73106 Page 172

1lt DALSTON-TLAB Page 177

1lt 81896 Page 180

1lt 94350 Page 172

1lt 100166 Page 178
Provence & Chatsworth 1lt 103378 Page 178

1lt 82114 Page 180

1lt 94358 Page 172


Gerik 1lt 95473 Page 196 Karna 1lt 107527 Page 196

Brair 1lt 106336 Page 193

Raskin 1lt
EH-RASKIN-TL Page 185

Hiero 1lt 93140 Page 177

Hoop 1lt 91934 Page 48

1lt 95456 Page 75


1lt 95460 Page 185


Brodey 1lt 96598 Page 190


1lt 78705 Page 197


1lt 95464 Page 197



1lt 95470 Page 197 Balin 1lt 95459 Page 185



Largo 1lt 95478 Page 198

1lt 98752 Page 38

1lt 652-TLAN Page 174 inc

5lt 76562 Page 203



1lt 76645 Page 191
1lt 98747 Page 38 Range 1lt 652-TLSC Page 174 inc

5lt 76568 Page 203

1lt 77859 Page 22 Hansen 1lt 77861 Page 21 Hansen 1lt 91740 Page 21



1lt 76646 Page 191 Hackney 1lt 656-TL-SC Page 198 inc Hackney 1lt 656-TL-AN Page 198 inc

3lt 76567 Page 203


3lt 76731 Page 76


1lt 76983 Page 74

1lt 100043 Page 40

1lt 90561 Page 198

1lt 92879 Page 55


1lt 91744 Page 72

1lt 95468 Page 192

1lt 76613 Page 72

1lt 90521 Page 192
1lt 77860 Page 22 Hoop 1lt 98095 Page 48

1lt 100045 Page 40


1lt 100863 Page 193

1lt 91741 Page 21

2lt 92219 Page 54

1lt 77862 Page 21

1lt 90557 Page 75

3lt 91974 Page 43 Dimple 1lt 97978 Page 43


3lt 76723 Page 59
2lt 76123 Page 45
Dimple 1lt 98271 Page 43 Talia 2lt 77569 Page 44 Highclere 3lt 94359 Page 78
3lt 94378 Page 78
3lt 98935 Page 81 Altesse 2lt ALTESSE-FLNI Page 204



























































































Page 211



8” 94362 Page 211























































































































































































































































































Warm white 2000K - 3000K
Warmer white light is generally preferred for creating a more relaxed environment in living spaces, dining rooms, reception areas.
Cool white 4000K & Daylight 6500K
Cool white is a great choice for domestic areas where simulated natural light is preferred. Daylight is cooler still and, depending on your preference both are perfect for task areas, such as kitchens, bathrooms and utility rooms.

Protected against a solid object greater than 50mm such as a hand.
Protected against a solid object greater than 12.5mm such as a finger.
Protected against a solid object greater than 2.5mm such as a screwdriver.
Protected against a solid object greater than 1mm such as a wire.
Dust protected. Limited ingress of dust.
Dust tight. No ingress of dust.
Zone 1 - Above the bath or shower to a height of 2250mm. All lights fitted within this area must be a minimum of IP44 rated. Where a shower head is above the bath IP65 should be used. Lights must be protected by a 30mA RCD if supplied at mains voltage.
Zone 2 - 600mm outside of Zone 1 and a 600mm radius above washbasins. All fittings in this area should be a minimum of IP44, unless there is a danger of direct water jet spray in which case IP65 rating is required.
Outside Zones/Zone 3 - There are no special requirements in this zone in the UK. In Ireland Zone 3 requires IP rated products.
Protected against vertical falling drops of water. Limited ingress permitted.
Protected against vertical falling drops of water with enclosure tilted up to 15° from the vertical. Limited ingress permitted.
Protected against sprays of water up to 60º from the vertical. Limited ingress permitted.
Protected against water splashes from all directions. Limited ingress permitted.
Protected against jets of water.
Protected against powerful jets of water.
Watertight against immersion in water between 15cm and 1m for 30 minutes.
Watertight against immersion in water for long periods.
AHERNE-5CH 152
ALDA-3CH 152
ALDA-5CH 152
Product code Page
CICI-10IV 209
CICI-12GRY 209
CICI-12IV 209
CICI-14GRY 209
CICI-14IV 209
CICI-16GRY 209
CICI-16IV 209
CICI-18GRY 209
CICI-18IV 209
CLEF-BAR-3CH 155
COLMAN-BL 141
CORVINA 111
CORVINA-1WB 111
DALSTON-TLAB 177
DOMINA-1WBNI 158
DOMINA-2WBNI 158
BOYER-3AB 98
BOYER-3CH 98
BOYER-5AB 98
BOYER-5CH 98
BRIO-1WBAB 88
BRIO-1WBCH 88
BRIO-3AB 88
BRIO-3CH 88
CAGNEY-1WBAB 109
CAGNEY-1WBSC 109
CAGNEY-3AB 109
CAGNEY-3SC 109
CAGNEY-5AB 109
CAGNEY-5SC 109
CAMILLE-24CH 68
CANNING-TLCH 174
CARLA-10 211
CARLA-12 211
CARLA-14 211
CARLA-16 211
CARLA-18 211
CARLA-22 211
CARLA-6 211
CARRIE-12 212
CARRIE-14 212
CARRIE-16 212
CARRIE-18 212
CARRIE-22 212
CELIA-12 212
CELIA-14 212
CELIA-16 212
CELIA-20 212
CHASSELAS 111
CICI-10GRY 209
Product code Page
KORA-8AB 138
KORA-8CH 138
LANGELLA-1WBCH 99
LANGELLA-3CH 99
LANGELLA-5CH 99
LULLABY-3CR 138
LULLABY-5CR 138
MARCONI-2WBCH 158
MARCONI-2WBLI 158
MARSHAM-TLIV 179
MARSHAM-TLTA 179
MONACO-AN 205
MONACO-SC 205
MORETO 110
MORETO-1WBCH 110
MOTOWN-4CH 152
EH-LEAF-TL-L 187
EH-LEAF-TL-S 186
EH-NAUTICAL-FL 204
EH-RASKIN-TL 185
EH-SIMETO-TL 185
EH-STORNI-L 120
EH-STORNI-S 120
EH-TANARO-AB 126
EH-TRIPOD-FLBL 204
EH-TRIPOD-FLDW 204 EL-40045
MUNI-CH 66
MUNI-CH-F 66
MUNI-CH-S 66
MUNI-CO 66
MUNI-CO-F 66
MUNI-TLCH 66
NIRO-10MULTI 135
OSLO-FL-AN 199
OSLO-M-AN 199
OSLO-S-AN 199
PHANTOM-7CH 138
PL-LEDG9-AN 161
PL-LEDG9-SC 161
PL200-E14-SWAN 161
PL350-E14-SWAN 161
FARGO-12BP 61
FARGO-12CH 61
FARGO-14BP 61
FARGO-14CH 61
FARGO-18BP 61
FARGO-18CH 61
FARGO-BP 61
FARGO-CH 61
FARGO-WBBP 61
FARGO-WBCH 61
FIENNES-1WBNI 100
FIENNES-5NI 100
HUDSON-2WBCH 58
HUDSON-3CH 58
KEW-TLGO 177
KLINE-2CH 137
KLINE-3CH 137
KORA-5AB 138
KORA-5CH 139
WELLES-1WBSC
WELLES-3AB
PL350-E14-SWBP 161
PL350-E14-SWCH 161
POLKA-AB 141
POLKA-SN 141
ROME-AN 205
ROME-BC 205
ROME-CH 205
ROME-SB 205
ROME-SC 205
S-104001 267
S-104002 267
SC-7 213
SC-9 213
TRAMINI 185
UG-WB-A 159
UG-WB-G 159
UG-WB-X 159
VERDONE 172
VILANA-TLGO 177
YG-6001-SS
YG-6002-SS
YG-6003-SS
YG-7501
YG-861-SS 253
YG-862-SS 253
YG-863-SS 253
YG-865-SS 253



Endon designers take great care with the colours used in the Directory. The limitations of the printing process may mean a slight variation in colour. Every reasonable care has been taken to ensure the reproductions are accurate. Descriptions in the catalogue are approximate only. Due to the nature of the product and its manufacture, there may be variations in materials, colour, size and finish.
Our natural stone, marble and concrete products are sold on the basis of your acceptance of the terms of this disclaimer. All these types of products contain natural stone elements and there will be variations in texture, colour, veining and patterns. These variations are not flaws, they create the uniqueness of each product. Please note that the appearance of the actual products may differ from the images shown due to these variations.
We always seek to improve our product and reserve the right to make changes at any time without notice. This catalogue supersedes all previous issues.
Endon Lighting are proud to be partnered and associated with the organisations shown below.

All copyright, design right and other intellectual property rights in our designs and in our products (and in the images, text and design of this brochure) are and will remain the property of Endon Lighting Ltd. Any infringement of these rights will be pursued vigorously.
We are doing everything we can to be as green as possible. Our paper is FSC®-certified, meaning it is sourced with responsible forestry practices. Additionally, we are carbon balanced by the World Land Trust, so we reduce the impact of our carbon emissions. On top of that, our printer W&G Baird, uses vegetable-based inks, furthering our environmental sustainability.

